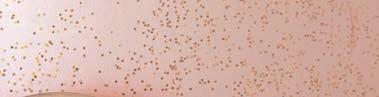

Wow factor remains

For the past month, I’ve seen Queenstown through the eyes of a visitor, which has been a refreshing way to remember how incredible it is to live here.
It’s pretty easy to become fixated on the tangle of problems the town has, from affordable housing, to staffing, burnout, the maze of cones, bus cancellations, traffic, rising living costs, fights over property development and the future of the airport, etc. etc. all angrily debated online. Despite some of these problems making international headlines, as soon as the borders reopened, our family overseas were keen to visit and booked flights when Covid restrictions eased and prices were no longer stratospheric. First up was my mother, who picked a good month to see Queenstown and its community at its best. In November, she managed to cram in our citizenship ceremony, two birthdays, the Queenstown Marathon, a trip to Riverton and Milford Sound, iFly, and enough restaurant lunches and dinners to disappoint the Reserve Bank.
I know from talking to business owners, staff and attending Chamber of Commerce functions, that the majority of hospo and tourism businesses are massively understaffed and exhausted. But they appear to be hiding it well. The restaurants were generally flawless and in tourism experiences staff still seem to be going above and beyond.




Take iFly, for example, an early Christmas present from grandma for my daughters. Our six-year-old was reluctant, then wanted to give it a go, but then once airborne, decided it wasn’t for her. This could have easily turned into a negative experience for everyone but the staff were so patient and positive. They tried to make it work, shuffling things around, and then when it didn’t, offered us the option of a refund or our other daughter using the minutes.
Queenstown Marathon was the same, even the guy on the carpark at Warren Park was jolly. The Rifters Gin was a hit, as was Ferg’s commentary, and the general organisation and vibe. Pure Milford delivered too, on a wet and windy day. Mum even went for a solo walk around downtown, and despite being nearly 70, with sight issues and using a cane, managed to navigate around the cones. Downtown appeared much more spacious, she said, thanks to the new pedestrianised zones, such as Lower Beach St, although she did notice a lot of the restaurants were closed at lunchtime. There might have been more negatives had she been staying in a hotel or using public transport but for now, coming after a long winter season when there were more than a million ski visitors, the town appears to be coping well, at least from a visitors’ viewpoint. A busy summer will be another huge test but I’m sure Queenstown will rise to the challenge, and ultimately get through the pandemic-hangover without any reputational damage.
Paul Taylor | Queenstown Media Group









WATERFRONT | STEAMER WHARF Open Christmas Day +64 3 442 4600 WATERFRONT | STEAMER WHARF +64 3 442 4600 +64 3 442 4600 Come celebrate NYE with us!
No 880 6 Dec12 Dec LAKES WEEKLY LOCALLY OWNEDSINCE FOREVER BULLETIN
Jo Anderson and Maree Aoake were honoured by Victim Support NZ last week for their outstanding service as volunteers. Jo was awarded a special Outstanding Service Award and Maree was recognised for 17 years serving Victim Support in the Wakatipu. See story on page 12.
By Sue Fea

The historic MV Pembroke vessel, built in 1962 for the Government’s Tourist Hotel Corporation to cruise Milford Sound, has just celebrated its 60th birthday, and is still going strong.

Owned by 10, mostly local, partners since 2010, including Derek and Anna Brown, Greg and Janie Turner, Greg Hay, Trapper and Annelise Davis and Wayne and Julia Foley, the Pembroke is still cruising Dusky and Breaksea Sounds in Fiordland with its 1976 motors still in good condition.
The Browns, Greg (Hay) and Trapper bought the boat in late 2003 off a retired Auckland engineer who had spent four years restoring it to its former glory. Prior to that it had been converted into Fiordland’s first dive charter boat by Kathy Jamieson, who bought it off the THC in 1986, says Derek. “It was originally built for these waters so is well suited to Fiordland,” he says.
The Pembroke did two-hour tourist trips at Milford from the early 1960s.

The Browns, who now operate the Pembroke with managers based in Te Anau, first started Fiordland Charters in 1997 with their first boat, the Esprit de Mer, which they sold in 2001.
After teaming up with Greg (Hay) and Trapper to buy the Pembroke for partly private, partly commercial use, demand was such that the commercial arm grew quickly and the other partners came on board, including the current managers, Paul and Katherine Mitchell.


The super strong, 58-foot (17.6m) boat was built out of Corten steel and weighs in at 50 tonnes, with original restored wood features throughout its interiors.
The original design plans and drawings have been put together into a special celebration book outlining the Pembroke’s colourful history and this will remain on board. The plans will likely then be donated to a local museum. A special celebration was held on board the boat on December 1 with the owners flying in former owners, staff, and people who worked on the Pembroke during its time on Milford Sound.
Guests are mostly New Zealanders and Derek says bookings have been steady throughout the past few years, despite Covid restrictions. The usual charter period is for three to seven days cruising around Dusky or Breaksea
Sounds, fishing, scuba diving, kayaking, hunting and exploring the rich history of the surrounding fiords on foot.
The Pembroke comfortably accommodates eight, plus two crew, including a chef, with the food on offer a big attraction. Any fresh catches of the day, whether that be blue cod, hapuka, tarakihi, butterfish or crayfish, are served up that night on board. Guests are helicoptered in and out and Derek says the wildlife, scenery and history is a big attraction, with many family groups also making the trip. Humpback whales often pass through and guests love to explore little islands where they sometimes spot a rare native bird species. “There’s a lot of early European and Maori history around Dusky Sound where Captain Cook was for six weeks in 1773,” says Derek. New Zealand’s earliest bird conservation work was also done there in the late 1800s and early 1900s and guests are keen to explore the old relics.
LAKES WEEKLY BULLETIN Page 2 CONTENT LIST 24-25 Goings On About Town 30 Gardening with Dr Compost 26-27 Hospo Guide 9 Process begins for urgently needed facility 8 Drug checking for summer 16 Train Your Brain 19-21 Christmas Functions 13 Tit Bits From around the world 12 Unsung Heroes Honoured 11 Poll Questions 17 Queenstown rental crisis squeezes town’s most vulnerable 18 World affairs on the agenda 28-29 QT Business 4 Fast-track rejection for Ladies Mile developer News 10 My Life Story Joan Allan - Acting The Goat 22-23 Arts and Culture A Christmas adventure around the Whakatipu ACAS first Arrowtown “Art Before Dark” Open Gallery Event 6 Community Notes International Volunteers Day
Fiords
MV Pembroke Marks 60 Years Cruising The

Fast-track rejection for Ladies Mile developer
By Paul Taylor
Plans for major housing development along Ladies Mile have been rejected by the Government’s fast-track planning panel.
Flint’s Park is the first of three residential subdivisions along Ladies Mile to be considered under the COVID-19 Recovery (Fast-track Consenting) Act 2020 (FTA) pathway.
It speeds up the process of gaining recourse consent.
Developer Glenpanel Development Ltd, owned by directors Mark Tylden and Lindsey Topp, applied to build up to 384 homes on 15.6ha of land beneath Slope Hill, at 429 Frankton-Ladies Mile Highway. But the panel, administered through the Environmental Protection Authority, has declined the application citing local planning rules, along with the impact on the landscape and traffic.
Developers behind the massive Lakeview project in downtown Queenstown are also going through the fast-track process.
Last week, they submitted amended plans, reducing the height of their buildings by up to nine metres, after the panel indicated the original plans would not be approved.
The revised plans remove hopsitality and recreation facilities from the public podium level, and reduce the internal ceiling heights of apartments. A final decision from the panel is expected next week.
On Flint’s Park, Tylden says he’s disappointed with the decision which “fails to take into account the chronic lack of housing in Queenstown which is hampering our local economy”.
“Taking a broader view would have meant taking into account the businesses that simply cannot get staff and the people who cannot get a house to rent, let alone buy a house,” he says.
“Unfortunately this broader view was not taken and Queenstown’s housing shortage and worker shortage will continue until something serious is done about housing supply.
“Housing costs already mean the coming tourist season will not have enough staff for businesses to operate at full capacity, and there appears no real chance of the 2023/24 summer season being any better.”
The panel’s decision says it accepts the project would have a number of positive effects, such as the provision of additional housing in an area that has a housing shortage and, consistent with the purpose of the FTA, the generation of employment.
It also recognised that flat land north of Ladies Mile / State Highway 6, currently zoned rural land, is earmarked for urbanisation by Queenstown Lakes District Council’s spatial plan and Ladies Mile Masterplan, through an expansion of the Urban Growth Boundary (UGB).
However, the panel said the council’s proposed district plan states that urbanisation shouldn’t happen until the UGB is expanded.
And, it said, the expanded UGB would not cover the whole site. It excludes Slope Hill, which is protected within an Outstanding Natural Feature zone.
“The project will have adverse effects on the environment that are more than minor,” the decision reads. “Specifically, the panel has determined that the project will have adverse landscape and visual effects and adverse traffic and transport effects that are more than minor, including when taking into account potential mitigation.”
It also said the geotechnical and stormwater information supplied by the developer was inadequate, although that was not a decisive factor in refusing the recourse consent application.
The project could also have featured a primary school, reducing the number of homes to 179, along with an early childhood centre, a mixed-use centre including a café, shops and offices, and public open space.

Both Transport Minister Michael Wood and Waka Kotahi raised concerns in submissions about the impact on traffic of development along SH6.
The panel’s decision can be appealed to the High Court only on questions of law.
Glenpanel Development Ltd’s Flint’s Park West is another Ladies Mile development which will go through the fast-track process. It is on an 18.4ha site, although only 8.6ha would be developed, featuring up to 315 homes. There could also be a primary school, church and public open space.
And Glenpanel on Ladies Mile, by separate developers Maryhill Ltd, is also going through the fast-track consenting process. That could feature up to 748 homes, as well as a park-and-ride facility and a new primary school, creating up to 313 jobs.

The three developments considered for fasttracked consent, Flint’s Park, Flint’s Park West and Glenpanel.
Image: Glenpanel Masterplan
LAKES WEEKLY BULLETIN Page 4
Flint’s Park concept plan. Image: FPA application
How about a beautiful Angus Watson 2023 Art Calendar.



Available online at AngusWatson.com















LAKES WEEKLY BULLETIN Page 5
Can’t think of a Christmas Present?
Mon/Fri - 9:30am-5:30pm Level 1, Stratton House (below Sky City) 24 Beach Street, Queenstown WATCH REPAIRS NOW 25-50% OFF XMAS WATCH SALE ALL WATCHES Seiko, Casio, Royal London, Boccia, Cannibal, Rosefield and Jacques Lemans Sales ends 23rd December, 2022 Only stock in store and no Rain Checks STRUGGLING TO FIND THAT UNIQUE CHRISTMAS PRESENT FOR YOUR LOVED ONE? Everlasting Daisies has a wonder range of gifts, Christmas Decorations, ornaments and trees! Unit D/1091 Frankton Rd (BP Roundabout. Next door to Post Office) Phone: 03 441-4689 or 021 326 793 or email: dibowbyes@everlastingdaisies.co.nz Personalised gift baskets can be custom assembled to reflect your specific tastes. Visit the mini paradise full of treasures and judge for yourself! Contact Andrew for a free quote: Phone: 0210 416 912 | Email: andrew@pounamultd.co.nz Lawn & Garden Maintenance Fencing / Retaining Walls Excavation / Earthmoving Working at Heights to 15m Tree Felling Stump Grinding Log Splitting Mulching Get in touch today for a free, no obligation quote. Phone: 027 209 8455 | Email: alex@remarkablecoatings.co.nz www.remarkablecoatings.co.nz RESIDENTIAL AND COMMERCIAL PROPERTYMANAGEMENT IN PARTNERSHIP WITH If you have an investment property - contact us today! The Accommodation Centre | 03 442 7777 | reception@tacc.nz We service the wider Central Otago area! Queenstown, Arrowtown, Wanaka and Cromwell Queenstown based and across wider Central Otago Longest serving PM company in QT / Central Otago High level of experience and expertise Personal points of contact: • Wanaka / Cromwell: Melanie Moore • Queenstown / Arrowtown: Nathan Gee / Chloe Holliday • Interviewing and carefully checking potential tenants –strict screening process • Managing applications and bond lodgements and refunds • Thorough and regular property inspections • Positive and regular interaction with tenants including regular tenant surveys • Managing your tenancy risks including regular updates on tenancy law and regulations changes
COMMUNITY NOTES

International Volunteers Day



 by Juliette Hicks, Volunteer South
by Juliette Hicks, Volunteer South
December 5th is International Volunteer Day and Volunteer South is the local connection bringing volunteers and organisations needing help together. This week is a chance to celebrate volunteers and the change they bring about in their communities. Beth Lyons is one of those locals giving her time for the betterment of the community.
A delicious three course meal made entirely from rescued food set Beth Lyons on her volunteer journey.
“I attended a dinner where KiwiHarvest and Sustainable Queenstown made a meal from kai that had been rescued from local supermarkets, restaurants and cafes” says Beth. “I liked what I heard about KiwiHarvest, and began volunteering for them and now I help rescue and redistribute food too.”
In Queenstown the KiwiHarvest truck collects donated surplus food from the main supermarkets and in the CBD the KiwiHarvest e-bike, towing a trailer, collects from seven local cafes.

The perfectly good food is sorted, packed and redistributed to people in need through various local charities including the Salvation Army, Baskets of Blessings and Happiness House.
KiwiHarvest began as a food rescue charity in Dunedin. Today five branches around the country are engaged in collecting and redistributing over 8 million kilos of food. This food ends up on the plates of the 40% of New Zealanders who currently experience food insecurity.
Beth says “I love that KiwiHarvest ticks two boxes I’m passionate about - care for people and care for the environment. When we collect and redistribute food, we are part of a bigger process of reducing waste and redirecting it to people who are struggling to make ends meet.”
Born and raised in North Wales, Beth came to Queenstown with her partner Chris four years ago and were quickly smitten with the lifestyle, enjoying tramping, mountain biking and skiing “Our happy place is the backcountry. In Queenstown you really feel you can get out into the actual wilderness and tread the path not trod.”
Santa returns to Minus 5
 by Jessica Allen
by Jessica Allen
Future Bars’ Minus 5° Ice Bar will host Santa for their 11th annual fundraiser this weekend. The event raises money for Wakatipu Plunket by taking donations for a photo with Santa surrounded by his natural frozen environment.
Since the first event, approximately $20,000 has been raised. This year in addition to the photos there will be face painting at Steamer Wharf for a gold coin, with these funds also going to Plunket. You will have the choice of taking your own snaps or letting the friendly team take a picture, which you can then download later.

Future Bars Kristel Maroszek loves helping to organise the event each year and is looking forward to the weekend. She says “Plunket have a great lot of volunteers that have pretty much been doing this for the last decade or more and it’s just something to bring out all the families. A lot of people in the community have been coming to it every year to get that fun photo in the Ice Bar with Santa and just add it to their collection.”
The bar will be closed while Santa’s there, only open to those getting photos. Donations of $5 per child or $10 per family will be collected on the day with 100% of the proceeds going to Plunket. There’s also a colouring in competition – there will be a table set up outside the bar so children can complete their entries.
“We’ve all got kids of our own here so it’s really important that families are looked after. We love being part of this and Plunket have been great to work with. We love seeing kids getting stoked on it, and it’s a really




Presently working full time at Remarkables Primary, Beth also volunteers for the Buddy Programme. “The thing about volunteering for both organisations is that it doesn’t take a huge time investment to feel like you are making a difference. It’s a couple of hours out of my week that are so uplifting.”
Beth’s belief in the importance of reducing waste has also been strengthened since joining KiwiHarvest. “When we pick up and sort a box of food we don’t know exactly who it will be going to. That’s part of the charm. We do know it will be very much appreciated.” She would love to see KiwiHarvest grow into more areas.
Thinking about volunteering? Beth says “Just try it. You will meet lovely like minded people and realise that small actions really can make a big difference.I love telling people about volunteering at KiwiHarvest. It’s just so positive.”
At Volunteer South - Central Lakes, we can discuss your skills and goals for volunteering and help make the perfect match. For more information about volunteer roles with Kiwi Harvest go to www.volunteersouth.or.nz

unique way to see Santa, especially here in the warmer climate,” says Kristel.
Pop down to Minus 5° on Saturday 10 or Sunday 11 November between 10am and 2pm to meet Santa in the icy environment and to support a great cause.

GET YOUR PIC WITH ST NICK IN HIS WINTER WONDERLAND STEAMER WHARF, QUEENSTOWN LAKEFRONT | NO BOOKINGS REQUIRED DONATION: $5 PER CHILD OR $10 FOR YOUR FAMILY! ALL PROCEEDS GIVEN TO PLUNKET QUEENSTOWN sat 10th - sun 11th december / 10am-2pm daily sat 10th - sun 11th december / 10am-2pm daily plus fun activities!

















































LAKES WEEKLY BULLETIN Page 7 • Health Monitoring – on site • Pre-employment health assessments • Drug testing, we have a mobile unit • Respirator / P95 mask Fit Testing • Workplace Healthy Heart, Cardiac Risk Assessment, programme • Ergonomic Assessments 18 Glenda Drive, 03 442 3682 / 027 442 3682 www.engagesafety.co.nz COVID RESPONSE • VACCINATIONS • SWABBING • FIT 2 FLY supervised RATs and PCA TESTS HEALTH AND SAFETY PLANS and AUDITS QUEENSTOWN FIRST AID NZQA unit standards 6400, 6401, 6402 Highland Real Estate Group Ltd Licensed Agent REAA 2008 03 441 0777 FOR A RENTAL? SCAN QR CODE TO VIEW OUR LATEST LISTINGS! Looking Queenstown P 03 441 0777 E rentals.queenstown@harcourts.co.nz @arrowtown_memorial_pool *Closed Christmas Day & New Year’s Day. Season ends Sunday 5 March. P 03 442 0145 | E swim@qldc.govt.nz | W qldc.govt.nz/recreation @QLDCSportRec HEATED MAIN AND TODDLER POOLS OPENING MONDAY 5 DECEMBER 11.00AM TO 6.00PM* SEASON PASSES AVAILABLE THERAPEUTIC MASSAGE DIVINE REALIGNMENT ENERGY HEALING | REIKI HEALING | BI OPTRON LIGHT COLOUR HEALING, to rebalance and re energise PHONE PAULA FOR AN APPOINTMENT - 0211171389 www.naturalhealingpaulapetersen.com fbnaturalhealingpaulapetersen
Drug checking for summer
By Paul Taylor
People planning to take drugs this summer can have the substances checked by a free, legal and discreet service.

KnowYourStuffNZ drug checking clinics are available throughout Aotearoa, including Wānaka on 27 December, and are run in the spirit of confidentiality and evidence-based, credible science.
“We’ve been operating since 2016, and in that time we’ve found that when we tell people that their substance is either not what they thought it was or contains additional, unexpected substances, more than half will then actively choose not to take it,” says Dr Brin Ryder PhD, from KnowYourStuffNZ.
“This in turn reduces drug-related harm because they’re not taking a highrisk substance. These findings are echoed by research in the UK, the US, and parts of Europe as well.”
In the 2020-21 season, only 69% of substances tested were what people thought they were. This is the lowest proportion to date since KnowYourStuffNZ has been running drug testing clinics.
Ryder says there is no moral judgement from the service.
“We are fair, even-handed, and respectful in how we give information, and who we give it to. We respect people’s confidentiality.”
The work KnowYourStuffNZ does is supported by health services, NGOs, and police as it is recognised as integral harm reduction work.
Dr Michael Butchard, Medical Officer of Health, National Public Health Service, says: “Harm reduction is a set of practical strategies and ideas aimed at reducing the negative consequences associated with drug use.
“Harm reduction acknowledges that people will choose to take drugs regardless of the law. KnowYourStuffNZ reduces harm associated with that use by providing factual, proven information to drug users about the substances they intend to take so that they can understand the risks and make safer decisions.

“This helps reduce the risk of people needing medical care as a result of consuming a substance that wasn’t what they thought it was.”
Ryder wants people to encourage anyone they know who is planning to consume drugs this coming summer, to go and get them checked, enabling them to make informed decisions about what substances they consume.
“We
Testing will be at Armstrong Room, Lake Wānaka Centre, 89 Ardmore Street, Wānaka, on 27 December, 12.30pm-7.30pm.
A full list of clinics around Aotearoa, including upcoming clinics in Dunedin, elsewhere in Otago, and Southland, is available on the KnowYourStuffNZ websiteevents page.
LAKES WEEKLY BULLETIN Page 8
“Our team are always happy to have a chat with you about the substance you bring in to get tested and answer any questions you might have,” says Brin.
are all about giving you the information to make more solid decisions about your own safety.”
Ecstasy comes in many forms. Photo: DEA
Process begins for urgently needed facility
By Paul Taylor
The Whakatipu Community Hub Charitable Trust (WCHCT) has received a conditional thumbs up for the facility, after presenting its case to Queenstown Lakes District Council (QLDC).

QLDC had recently identified excess land within the Event Centre masterplan and the WCHCT submitted an Expression of Interest to create a community hub. Council has a public process to follow which will now be undertaken, but the Trust Chair John MacDonald says the board is heartened by recognition that such a facility is needed and that its proposal was favourably received. At the presentation, MacDonald highlighted the needs of the social sector community for a purpose build environment where similar organisations could work together in a collective facility.
“Both QLDC and the Trust have identified the real difficulties faced by community organisations in securing long term affordable office rental and co-working spaces,” he said.
“With ever increasing rents and lack of suitable space, groups like Happiness House, Plunket and Queenstown Lakes Family Centre urgently need to find operational space that’s both permanent and suitable.”

MacDonald explained to council that the success of a facility meant it had to be central, accessible, and future proofed for the growing community.
“We need a location with good bus routes and close to the facilities that locals use. The Trust had identified Frankton Flats as our preferred location. We are hopeful the process will secure this community land for this purpose and co-purposes such as providing a central social hub to support Civil Defence resilience plans. Covid showed us the importance of a community place where people can go for support and help.”
Jane Guy, Business Manager, Central Lakes Family Services, supported the bid and reiterated to the Council the urgent need for this community facility.
“We desperately need modern bespoke facilities. We are constantly having to help people in our community from cold offices with little or no meeting space. The hub will be an amazing asset to the community and the opportunity to collaborate with other agencies and charities in the same location. This will be invaluable for us.”

A council decision on a draft lease is expected early next year. In the meantime, the Trust continues its planning work which continues to include extensive research into community needs, looking at similar facilities elsewhere and investigating fundraising options.
Further information about the Trust is available on the website www. whakatipuhub.org.nz
LAKES WEEKLY BULLETIN Page 9
FIND THE PERFECT GIFT THIS CHRISTMAS STOCKINGS STUFFERS, PERSONALISED LABELS ACROSS OUR GLENFIDDICH RANGE, WINE SETS, GIFT WRAPPING DONE FOR YOU AND SO MUCH MORE!
The Kollective in Tauranga is a similar concept
M Lf Soy







 by Sue Fea
by Sue Fea

JOAN ALLAN ACTING THE GOAT
The daughter of a Swedish journalist and Kiwi miner, Joan Allan, was born near Greymouth, moving with the family to Dunedin, aged three. Hijinks and hilarity have always been who she is, ordered off the Otago Girls’ High School stage for hysterically laughing while reading a Greek poem. Sadly, Joan’s parents parted when she was 12 and Joan and her brother grew up around the Evening Star newsroom in Dunedin. Her mum covered many a Royal Tour, getting to know many famous people, including Princess Diana’s father.
A year into her nursing training Joan switched to dental nursing. One summer a fellow student brought her home to Cloverdale farm, in Lower Shotover, for a holiday, aged 20, where she met husband Jack. They married in 1956. “We’d go to balls at the Shotover and Arrowtown halls, stagger home exhausted, get changed, fill up with coffee and head straight out to milk the cows,” recalls Joan. A ‘city girl’, Joan had to learn fast. “A farmhand was away once and I went to help, leg-roping the ‘cow’ in for milking, when the other farmhand said, ‘That’ll be a dry argument. I’d legroped the bull,” she laughs. The Allans milked for the town supply, their Chevy truck laden with milk cans, usually filling old beer bottles for the campers at Queenstown Camping Ground. Everybody seemed to be related back then. “I didn’t dare say a word about anyone,” she says. Jack’s mother Jessie Allan hailed from the first family on Crown Terrace. Her mother, ‘Granny Mackie’, had the same boarder for 67 years – King Butler. “He had only one canine tooth left and I itched to take it out,” she grins.
A great debater, Joan was a foundation member of Queenstown Toastmistress Club. She loved a prank, pulling one over the audience at a community debate arranging for former deputy mayor Margaret McHugh to stride into the hall in anger at the stench of Joan’s pet goat, Thelma, on stage. Joan would regularly perform as ‘Mrs Abominable’ at shows, giving the council a ribbing
in jest, and more seriously on political issues at meetings when required.
Ever the hostess, Joan was the first to host home stays and farm tours locally, during the 1980s. A delegation of highranking Chinese officials arrived by bus once, but Joan’s fiercely protective pet goat Mace holed them up in the bus.


“Another time Arrowtown Fire Brigade came to check our water supply and Mace charged them, sending them racing up trees and hiding behind buildings.”
She’s hosted famous people from around the world, including renowned White House journalist Connie Lawn, and NASA science greats, brightening many a day. There have been emergencies too, like the Jewish group that arrived after she’d prepared bacon and egg pie and ham salad for lunch.
Her spectacular, expansive gardens attracted many Japanese weddings from the 1990s. “My son’s father-in-law turned up with bag-pipes one day and they wouldn’t get out of the car they were so terrified,” says Joan.

The last of her four pet donkeys, Barty, only died recently at 26, and years earlier her huge pet pig, Delilah, produced so many piglets, they had to be topped up with milk and a drop of whisky then wrapped in Jack’s old underwear. “I’d pop them in the coal range oven to keep warm. One day the minister arrived and said, ’I can’t stand it, Joan. Whatever you’re cooking is still alive!’”

The three Allan kids rode horses and each year in the 1970s they’d rise early to trek with the local Pony Club to New Year camp on Mount Creighton Station. “I’d leave a freezer full of food for Jack and the workers and do so much baking, then Bill Dagg made us all rise at 4am before the traffic.”
A young Brian Dagg learned his lesson after sneaking an eel into Joan’s sleeping bag once, hauled in front of the class to speak while Joan taught communications skills at the high school. They’d ride on to the Glenorchy Races on New Year’s Day, where Joan once won the Barrel Race. “We’d ride all over the hills – the Sparys, Daggs, Allans, Thompsons and others, marching through town on the way home with people out on their balconies waving.”
At a fashion show and horseracing event on the Allan’s farm, Joan pipped Barry Thomas by a nose in the VIP Race, which she says he’s never forgotten.
A judge for the Lake Hayes Show Baby Competition in the 1960s, Al Spary was a clear winner, she says. “He was a big, cuddly baby, the biggest most beautiful baby ever. I was walking along singing ‘big ones, fat ones, thin ones’, then realised the speaker was on, sending that all over the showgrounds. I nearly died!” says Joan.
A bad stroke in 2003 affected her speech for a year, but Joan persisted with speech therapy, regaining it fully.
A former Arrowtown Golf Club captain, she’s still active as founder of the Wakatipu Garden Club, in Inner Wheel and the Queenstown and Districts Historical Society, and loves U3A and Book Club.
 Joan acting the goat on stage as Mrs Abominable in the 1980s
Joan in the 1980s with her donkeys and goats
Joan and her beloved pet donkey, Barty, who lived until 26. Photo: Jo Boyd
Joan acting the goat on stage as Mrs Abominable in the 1980s
Joan in the 1980s with her donkeys and goats
Joan and her beloved pet donkey, Barty, who lived until 26. Photo: Jo Boyd










LAKES WEEKLY BULLETIN Page 11 GET CASH FOR YOUR UNWANTED VEHICLES Kiwi owned and operated DAMAGED, MECHANICAL ISSUES DEREGISTERED, CRASHED NO WOF - NO PROBLEM WE BUY ALL CASH FOR YOUR UNWANTED CAR, VAN, UTE, TRUCK, 4WD ETC. Call today for a free Quote 0800 333 422 | 027 233 3533 WE ALSO SELL A WIDE RANGE OF CAR PARTS FOR MOST MAKES AND MODELS INCLUDING ENGINES, WINDSCREENS AND TYRES Send a photo of you with the LWB around NZ to info@qmg.co.nz and be in to Win a Meal Voucher (regular burger, chips & drink) Tom Metzger at Purakaunui Bay reading the LWB. Congratulations! You won a meal voucher. Come and pick it up from the Lakes Weekly office. LAKES WEEKLY POLL LWB regularly polls locals on issues affecting our region. This weeks responses are below. There were 123 respondents this week. If you would like to take part: you can sign up on the LWB Facebook page. Would you support a windfall profits tax being introduced for supermarkets, banks, energy companies and other corporations? How often do you order a meal via a home delivery service? Yes - 59% No - 15% Unsure - 27% Weekly - 7% Monthly -
Never - 60% Last Week - 21% Last month - 27% Can’t remember / Not applicable - 52% Unsure Monthly Weekly Never No Last Week Last month Can’t remember / Not applicable Yes No Unsure Yes No Unsure Yes When did you last visit the CBD for a night out? Do you agree with downtown’s more pedestrian friendly zones approach? Should New Zealand pay compensation to developing countries ford amage caused by climate change? Yes - 71% No - 15% Unsure - 14% Yes - 20% No - 60% Unsure - 20% How to advertise Ph: 03 409 2800 Email: info@qmg.co.nz Place your ad online: www.lwb.co.nz Advertising Deadlines Display Advertising: 12pm Friday Situations Vacant: 12pm Friday Queenstown Media Group 2nd Floor, The Mountaineer Building Cnr Beach and Rees Street PO Box 1546, Queenstown 9300 Meet the team David Gibbs General Manager Kendalle McLeod Finance Catherine Mercer Account Manager 027 777 2785 | cat@qmg.co.nz Kylee De Suza Account Manager 021 044 2968 | kylee@qmg.co.nz Ana Paula Salvi Graphic Designer Patricia W. Becker Graphic Designer Paul Taylor Editor/Journalist Sue Fea Journalist Bethany Rogers Contributor Lauren Prebble Contributor Jay Cassells Contributor
33%
UNSUNG HEROES HONOURED
By Sue Fea
Two local unsung heroes have been honoured by Victim Support NZ for their volunteer efforts, going above and beyond the call of duty.
Jo Anderson was awarded a special Outstanding Service Award by Victim Support NZ Chief Executive James McCulloch in Queenstown on Thursday (Dec 1). He especially visited Queenstown to present the award for Jo’s manaakitanga (caring and commitment) to victims and families affected by the Christchurch mosque terror attacks. One of only two Wakatipu Victim Support volunteers specially trained to deal in homicide situations, Jo repeatedly travelled to and from Christchurch to offer support and assistance, says local chair Fae Robertson. “She was on the frontline, working with the mosque leaders and families, and the police, all entirely in her own time,” says Fae. Homicide trained volunteers not only give up their time to serve, but to train. “It’s very specific training which has to be renewed and updated every two years.”
Another local trooper, Maree Aoake, was also honoured by the local group committee for 17 years serving in the Wakatipu as a volunteer and 15 years on the committee. “She’s the most incredible volunteer, gentle and kind,” says Fae. Maree’s late husband Merv Aoake also worked in the field, counselling men through anger and violence issues at Jigsaw Central Lakes, and Fae says they made a great team.
Both women were presented with a plant to remember the occasion by in what was a total surprise at the Wakatipu Victim Support volunteers’ ‘thank you’ supper.

Queenstown Police Acting Senior Sergeant and Area Prevention Manager Steve Watts says both
women fully deserve honour and recognition. “Obviously the mosque shooting was a big ordeal and Victim Support provides a fabulous service supporting victims and their families through their hardship,” he says. Police brought in a lot of extra support from outside Canterbury and Jo was brought in as one of those. “She’s taken her own time to complete all the necessary extra training and help victims. Volunteers give their time to do this training and help the public through times of crisis and obviously the mosque attacks were a pinnacle crisis in New Zealand,” says Steve.
Support varied from phone conversations, organising formal counselling and funerals, to offering simple things like food bags to struggling families. “It’s taking care of the victim’s needs at the time and Victim Support steps up and even pays for the likes of accommodation and counselling. It’s a fantastic organisation.”
“We don’t celebrate our volunteers enough,” says Steve. “They give up their time – people like Maree giving 17 years of her time, to make our community a better place, to lift people in times of need and support them through their traumatic experience.”
Wakatipu Victim Support is continuously fundraising to cover the shortfall in funding. The annual Peony Drive raised $2180 early last month and Fae says as always so many locals turned out to bundle and deliver the 2180 stems. The Bannockburn grower always splits the $10 a bunch cost with Victim Support, taking only his costs, as yet another demonstration of the amazing generosity and support shown to the organisation each year, says Fae. “This community is just so incredibly kind,” she says. A taxi owner once
donated a $690 fare, driving a distraught accident victim and his five-year-old to Dunedin to be with his pregnant wife, who’d been airlifted. Workmen doing night repairs on the Kawarau Bridge years ago put planks of wood down to help Fae and another volunteer cross at 1.30am on their way home from helping accident victims.
A large proportion of Victim Support’s volunteer work is in assisting police during times of crisis offering practical, emotional and financial support, like emergency accommodation for victims and families affected by all manner of trauma. Volunteers, including Fae, have specialised bereavement training, and are called on in everything from family violence situations and accidents involving visitors, to sudden deaths and other tragedies. Volunteers can support people for some years through court processes and often follow up with victims at one and two year anniversaries offering a listening ear if it’s needed.
Jo Anderson, left was awarded a special Outstanding Service Award and Maree Aoake was honoured for 17 years’ service as a volunteer
The Council Word
Shelve your library fines
During December your local library will happily shelve fines in exchange for non-perishable food items, toiletries and gifts for children and adults. Each item waives $10 and donations received go to Happiness House (Whakatipu) or Glenorchy Community Food Bank. It’s a win-win!
Trails are for everyone
A friendly reminder to all trail users to keep left and give others plenty of room. If you’re on a bike, please use your bell or call out if approaching walkers or runners and slow down when passing. Take your rubbish home with you and keep dogs under control at all times.
Be wai wise this summer


Using water wisely at home can have a big impact on avoiding restrictions and protecting our reservoirs, so we’ve got plenty of water available for essential use or if we need to fight fires. Learn more about some simple tricks at qldc.govt.nz/waiwise
Transfer stations closed Sundays
Due to staff shortages our transfer stations will be closed on Sundays until 8 January. Please arrange your visits between 8.00am-5.00pm Monday to Saturday until then. This doesn’t affect your kerbside rubbish and recycling collections.
Arrowtown pool now open
Celebrate summer with outdoor swimming in our heated pool! Opening hours until Christmas are 11.00am-6.00pm daily. Save with a season pass! For more information drop by or visit www.qldc.govt.nz/recreation
Holiday programme bookings open
Queenstown Events Centre’s school holiday programme is now open for bookings. For more info including a daily schedule and how to book visit www.qldc.govt.nz/shp
Dogs in Queenstown Gardens
A friendly reminder that dogs must be kept on a leash in Te Kararo Queenstown Gardens. Some people, with and without their pooches, exercise and enjoy this space without wanting to run into another dog. Thank you!
Offering visitor accommodation?
There are rules you need to follow. Find more at qldc.govt. nz/services/rates-property/short-term-accommodation
www.qldc.govt.nz
Tit bits Tit bits
FROM AROUND THE WORLD
Another cryptocurrency lender goes broke
Cryptocurrency lender BlockFi, valued at $US4.8B, filed for Chapter 11 bankruptcy in the US last week, following this month’s collapse of cryptocurrency exchange FTX and its sister firm Alameda Research. BlockFi has more than 100,000 creditors, with the largest 10 creditors alone owed nearly $US1.2B, including $US30M owed to the US Securities and Exchange Commission, according to filings.

BlockFi, founded in 2017, is the latest digital asset firm to declare bankruptcy. BlockFi’s bankruptcy filing attributes its fall to intertwined finances with FTX and bankrupt cryptocurrency hedge fund Three Arrows Capital, previously one of BlockFi’s largest borrowers.
CNBC
Rolls-Royce tests hydrogen-fueled aircraft engine in aviation world first
Rolls-Royce used a converted AE 2100-A turboprop engine that powers civil and military aircraft to conduct the test in partnership with easyJet. It marks another step in the industry’s attempts to prove that hydrogen could play a viable role to help companies reduce harmful carbon emissions that contribute to climate change. Airlines are pushing to use more sustainable fuel as an alternative to petroleum-based jet fuel.
Flying is one of the most difficult industries to decarbonize, and technologies such as electricity or hydrogen-powered aircraft are still years from carrying a plane full of people over long distances.
Airbus plans to use a superjumbo A380 to test hydrogen-powered jet engines as part of a plan to bring a zero emissions aircraft into service by 2035.
Arstechnica
China-Directed
Bots Reportedly Spam Twitter
Search any major Chinese city on Twitter, and you will see a cascade of spam tweets that are published every few seconds, making it impossible to get any legitimate results.
There has been a “significant uptick” in these tweets recently, according to a China-focused data analyst. The surge in such bot content coincides with an unprecedented wave of protests that have swept across major Chinese cities and universities.
Discussion of protests is strictly censored on Chinese social media and protestors have turned to foreign platforms like Twitter and Telegram for communication which are banned in China and access requires the use of VPNs, which are also nearly extinct in local app stores.
The bot content on Twitter, which is thought to be governmentconnected, makes it even harder for Chinese citizens to organize demonstrations.
Tech Crunch
India - Scores injured as protest against Adani port grows
More than 80 people were injured in southern India as villagers continue to protest the building of a seaport being financed by Asia’s richest man, Gautam Adani.
The clashes came after a number of protesters were arrested by police while blocking access of construction vehicles to the Vizhinjam seaport.
The protests have gone on despite repeated orders by the top court of the state of Kerala to allow construction to start.
Construction of the $1,389 million ($US862 million) port has been halted for more than three months amid the protest by villagers who see it as causing coastal erosion and depriving them of their livelihoods.
LAKES WEEKLY BULLETIN Page 13
Dw.com
HIRE A HIVE.
Take your garden to the next level with your very own bees! We do the work, you get the honey. For more see tiakibees.co.nz, or call 021 090 75375
Lost & Found
LOST & FOUND
UNCLAIMED ITEMS SITTING AT THE POLICE STATION, at 11 Camp Street, this week include:
- TIMOTHY JAMES – WALLET
- JAMES EDERVEEN – WALLET
- VINCENT DUSTIN – WALLET
- BLUE SAMSUNG S8 PHONE IN TATTY black case, found along Arthurs Point Road
- IPHONE, WHITE AND RED IN CLEAR case
- HUAWEI PHONE IN BLUE FOLDING CASE, left in Taxi
- WHITE APPLE AIRPODS IN CHARGING CASE
- SILVER COLOURED MENS RING, LEFT AT Lakefront 20/11/22
- SILVER RING, WIDE WITH VERTICAL LINES and inscription on inside
- SILVER RING WITH 1 LARGE CLEAR stone and several smaller ones round the circumference
- SILVER NECKLACE (CHAIN), MICHAEL HILL BRAND
- EMERALD AND DIAMOND RING, LOCATED IN pocket of clothing donated to local charity
- MAXXIS BIKE TYRE, FOUND AT ARROW junction 29/11/22
- SONY CAMERA IN SOFT BLACK CASE, left outside the Station building
- SAMUEL SANDS – BLACK BAG

- CHARLIE SOVEA – BAG
Accommodation
ACCOM
KIA ORA FRENCH MALE, 38YO, SINGLE, NO kids, non-smoker, looking for a place to stay in town. $300/week. I will be working as F&B Supervisor in a hotel. fabien.delavie@gmail.com
A ROOM FOR RENT FROM 27TH FOR mature, clean, dog lover n non-smoker single in sunny warm Hanleys farm. $250 pw includes all the bills. 1 week bond required. Text 021 0263 8355
Services
SERVICES
COMPASSIONATE FRIENDS INVITE PARENTS, SIBLINGS, GRANDPARENTS OF bereaved children and their families to our Christmas Candlelight Evening to be held in the Alexandra Community House on Monday 12th December 2022. Time 7.00pm – 9.00pm. Bring a photograph or portrait painting of your loved one as well as a candle. Supper provided. Any enquires please phone Pauline 0273960611 (Central Otago Co-ordinator Compassionate Friends).

LAKES WEEKLY BULLETIN Page 14 • Upholstery • Loose Covers • Furniture • Marine • Automotive • Boat Covers • Blinds • Headboards • Fabrics Central Lakes Upholstery Ltd. 022 372 56 49 centrallakesupholstery@gmail.com centrallakesupholstery.co.nz20b McNulty Road, Cromwell 38B Gorge Road, Queenstown 03 442 8190 www.queenstownhealth.com QUEENSTO WN HEALTH Sports
- Sports Massage - Theragun - Cupping - Dry needling - Exercise Prescription For your health, wellbeing and active lifestyle...
Massage Therapy
SPCA OP SHOP – 51 GORGE RD. Open Monday – Saturday 9.00 – 5.00. Pre-loved goods and clothing at great prices. Help support the ongoing work done by the SPCA. Your old goods, or your time, could help save a life. Accepting donations (no electrical at the moment) and volunteers now.
WSCA – ROOMS FOR HIRE - SPACIOUS, sunny rooms are available for hire to Queenstown Community Groups. The rooms hold up to 90 people, with seated dining for 40. Located on the 1st floor of Malaghan House, 10 Memorial Street, Queenstown with lift access. There are kitchen facilities, toilets, Wi-Fi, media equipment for projection onto large screen plus large screen TV. Contact us on 03 4429214 or info@wsca.org.nz for more details.
WHAKATIPU DRIVE MY LIFE ARE SEEKING VOLUNTEERS to become mentor buddies to help our vulnerable people achieve their drivers licence. If you are interested or have any questions contact Louise Ward louise@reap.co.nz
For Sale
Clever Councillors Corner
FOR SALE:
PETS FOR SALE: NZKC REGISTERED PEDIGREE LABRADOR puppies whelped on Saturday 26 November. Blacks and Reds available. Sire and Dam have all their clearances, puppies will be NZKC registered. Can be viewed after 25 December, homed 21 January 2023. Inquiries please phone 0274 168 780
FOR SALE: V8I 1994 HONDA CROSSROAD (LANDROVER Discovery). Current WOF and REGO. Great condition and collectors item. Phone 02 500 028 for details and viewing.
EVERYTHING ELSE
Everything Else
AVAILABLE NOW ART STUDIOS, 10M2, FROM $70 per week, minimum 2 months at Te Atamira, Remarkables Park Town Centre. For more information please email hello@teatamira.nz
NEED AN IDYLLIC SPOT IN KINGSTON TO rent for your tiny home or caravan? Please text 022 404 3545.
HAVE THAT NIGGLING ACHE OR PAIN THAT just won’t go away? A recurring condition, or maybe you’re looking for something to assist alongside your more traditional treatments to speed up recovery? Two Feathers can help, an Alternative & Holistic Health Service including Tuning Forks, Energy Healing & Reiki Master. For more info contact Amy on: healing@ twofeathers.co.nz or 022 454 8288
HIRE A HIVE. HONEY FROM YOUR OWN backyard. We take care of everything, you enjoy the benefits. Hire-a-hive today at tiakibees.co.nz or call 021 090 75375
DESIGN SHOW! JOIN US FOR A GLASS of wine and view the beautiful new jewellery collections...Vu Jewellers
SUZI Q’S GARDEN.
Christmas Trees, fresh and fragrant are available for selection now. You’re welcome to visit and choose your tree which we’ll hold for your special day. Peony Rose Blooms are now available. No dogs or public facilities.
42D Gladmsuir Rd, Queensberry, SH6 Half way between Cromwell and Wanaka. Follow our Tree and Flower Farm Signs. Phone Suzi on 022 414 2301
SC PLASTERING LTD.
Craftsmen exterior plasterers - 20yrs local experience. Phone Shawn Cruise: 021 539 138 or skcruz@outlook.com
XS STORAGE
Secure self storage units – various sizes available Phone: 0800 297 786 | www.xsstorage.co.nz
Although he still didn’t always understand the words, he was now very glad of the birdsong on Hotop’s Rise - and that a year ago the wise councillors had allowed the trees to stay.

jakehassells.com
Art News
The Art Gallery of New South Wales Sydney Modern Project opens
Sydney Harbour is one of the most spectacular natural settings in the world. It’s also home to a handful of globally recognised landmarks. Jørn Utzon’s Sydney Opera House is one and the Sydney Harbour Bridge another. The Art Gallery of New South Wales’s new building, designed by Tokyo-based architects SANAA, hopes to join them.
The Sydney Modern Project opened last Saturday 3 December. The project is the largest transformation in the gallery’s 151-year history: bringing together a vast new building, new civic spaces, a unique subterranean exhibition space and a refurbishment of the original 19th-century Neo-Classical sandstone building.
The other key motivations behind the project were to provide the gallery with space to display more of the gallery’s collection of 36,000 objects, and to cater to constantly evolving forms of art.
Art Gallery of New South Wales director Dr Michael Brand said: ‘The new building, designed by Pritzker Prize–winning architects SANAA, almost doubles our exhibition space and, with a more porous connection between indoors and outdoors, delivers new types of spaces for new thinking and new forms of art.
Suspect Charged for Spraying Fake Blood at Toulouse-Lautrec Painting in Berlin
A suspect has been charged for spraying fake blood at a painting by Henri de Toulouse-Lautrec in Berlin’s Alte Nationalgalerie, according to a report in Monopol.
The incident was reminiscent of recent climate actions at European museums, however the prosecutor’s office announced on Tuesday that it has been deemed an isolated attack unconnected to any climate protection group. The suspect, a 53-year-old woman, was arrested on October 30 and has not offered a motive for why she sprayed the fake blood.
LAKES WEEKLY BULLETIN Page 15
is the ribbon on the Victoria Cross?
How many crotchets are there in a semibreve?

Nove is the Italian word for which number?

What is the device that controls an aircraft by instruments called?
Who starred as Ron Kovic in the 1989 film Born on the Fourth of July?
El Gordo is the lottery in which country?

Who played Betty Draper in Mad Men?
Who played Edina's mother in Absolutely Fabulous?
Which film series starred Vanessa Hudgens and Zac Efron? 12. Which song was the only UK no.1 single for The Four Seasons? 13. Which "mad" animal is associated with the month of March? 14. The Oktoberfest takes place in which European city? 15. Who recorded the 1971 song Maggie May? 16. March is named after which Roman god? 17. Which month represents a consonant in the radio phonetic alphabet? 18. What was Red October in the title of a 1990 film? 19. What title is given to the wife of an earl? 20. Who topped the charts in the 1970s with How Can I Be Sure and Daydreamer?


21. The Testarossa is a model of which Italian car? 22. What is the reading system of raised type for blind people? 23. The active volcano Cotopaxi is in which range of mountains? 24. What are male hares called?
25. Which US city hosted the 1996 Summer Olympics? 26. Which almond-flavoured liqueur is used to flavour tiramisu? 27. Basil, oil, Parmesan and pine nuts are the usual ingredients of which green sauce?

28. Which London church is the British Catholic Church's headquarters? 29. What is the name given to the crime of deliberately setting fire to property?
30. Which canine breed is named from the Welsh for "dwarf dog"? 31. What is the art of growing miniature trees in pots? 32. What is the birth sign of someone born on New Year's Day?
TRAINBRAIN YOUR ? LWB QUIZ CAPTION COMPETITION 3B Searle Lane www.hellpizza.com THE BEST DAMNED PIZZA IN THIS LIFE OR THE NEXT Send in your funniest Caption to be in the chance to WIN 1 x Double Pizza Voucher from Hell Pizza! Submit your entry via www.lwb.co.nz or our Facebook Page by 3pm Thursday. Answers in next weeks LWB SUDOKU I have four legs, but no hair. People ride me for hours, but don’t go anywhere. Without needing to be tugged or turned on, I always manage to be ready for work. What am I? RIDDLE 137985642 968724135 425613987 381257469 546839721 279146853 893561274 752498316 614372598 QUIZ ANSWERS: 1. Omelette | 2. July and August | 3. Purple | 4. Four | 5. Nine | 6. Autopilot | 7. Tom Cruise | 8. Spain | 9. January Jones | 10. Dame June Whitfield | 11. High School Musical | 12. December 1963 (Oh, What a Night) | 13. Hare | 14. Munich | 15. Sir Rod Stewart | 16. Mars | 17. November | 18. A submarine | 19. Countess | 20. David Cassidy | 21. Ferrari | 22. Braille | 23. The Andes | 24. Bucks | 25. Atlanta | 26. Amaretto | 27. Pesto | 28. Westminster Cathedral | 29. Arson | 30. Corgi | 31. Bonsai | 32. Capricorn RIDDLE: A desk Winner of the last Caption Competition is Louise Congratulations you won 1x Double Pizza Voucher from Hell Pizza. Collect your voucher from the LWB office. COMPETITION CAPTION Dare with Duck Tape 1. Frittata is an Italian version of which dish? 2. Which two summer months were named after Roman emperors? 3. What colour
4.
5.
6.
7.
8.
9.
10.
11.
SUDOKU ANSWER
Queenstown rental crisis squeezes town’s most vulnerable
By Tim Brown, RNZ Otago-Southland Reporter - tim.brown@rnz.co.nz

Renters in Queenstown are being forced into impossible decisions due to the housing affordability crisis.
Rental prices are skyrocketing with single-bedroom units going for as much as $500 or more per week, and landlords feel so emboldened they will often raise listed prices once they see interest in a rental.
There are also reports of some people living in cars or rough sleeping.
Dilip and Sangeeta Dahal moved to New Zealand from Nepal six years ago so Dilip could study.
The couple and their 8-year-old son had called Queenstown home for three years. But that could be about to change.
“We are so frustrated that we have decided we are going to move to another city next year. Maybe this year if we don’t find a house,” Sangeeta said.

“But we need to stick to here until we get our residency, then we have decided to move because we can’t be bothered with having to move house every single year.”
The family had little choice, she said.
“This is home for us now, like a second home. We don’t want to move but we are forced.
“Sometimes, I wake up at midnight to check the listings because I want to be the first to apply for a property. But it never happens - no luck.”

Queenstown was in the grips of a critical rental shortage.
Social media was filled with people crying out for homes and it was not uncommon to see basic three or four-bedroom rentals for upwards of $1000 per week.

After a year in their current rental home - which they could only afford because it was shared with flatmates - Dilip, Sangeeta and their son had to be out by 6 January.
“I have got the tenancy Act and that says they can give us 63 days notice to empty the house, but where is the humanity,” Dilip said.


“There is no humanity to be found for a family.”
And they could not just move.
Dilip had a Masters in Physics and worked as a high school vice-principal in Nepal. Sangeeta had a Masters in Management from the UK.
But he worked as a contract manager at a cleaning company and she worked at Bunnings, because they were unable to use their qualifications here.

His visa was sponsored by his employer, so they could not relocate to a cheaper city.


And while Dilip applied for residency in March, it was still being processed leaving the family in limbo and with real fears about what would happen come January.
“If it was only the two of us we could stay anywhere, like in a car - anywhere,” Sangeeta said.


“But with a kid, it’s really hard. We haven’t thought about what’s next because we don’t want to have to go that far. It’s really stressful.”
Happiness House manager Léna Boss said they were not alone.
The need for housing was the worst she had seen and it was growing. People were coming into the community support centre in dire situations, Boss said.
“People who have been living in hostels for the past few months, people who are living in their cars, people living outside sometimes as well - in the streets - that’s happened.”

Short-term letting was further driving the crisis.
About 1500 homes were listed on Airbnb and one in 16 of all households in the Queenstown Lakes district was now on the Queenstown Lakes Community Housing Trust’s waiting list for an affordable home.

Wigmer Silva was one of the Queenstown’s lucky residents.
After months of hunting, he had managed to find a rental after going to countless viewings and competing with dozens of people at each.
He believed greed was to blame.
“People need to have a little more respect, more compassion for others because it’s not just about what’s in your pocket. We’re all here trying to make the machine run. We want to work, we want to live, we want a little bit of dignity, we want to have a home to sleep. I don’t think we’re asking for much,” Silva said.
Matt Wong, a recently elected Queenstown Lakes District councillor and owner of tourism business iFLY, said the rental crisis was exacerbating the district’s worker shortage.
“We’re hearing it from different sectors of the community. So from the young workers that are actually living here now and they are getting moved on from their short-term accommodation and they’re finding it extremely difficult to find permanent long-term accommodation and that’s extremely challenging, especially because prices are going right back up to where they were before.
“The second thing we’re hearing from employers who are trying to employ people coming into the district, and the one thing that’s hamstringing the new employers, is they can’t find anywhere to live. So they only last here a couple of weeks, they find it extremely challenging to find a place and they move on.”
There was no silver bullet and the council needed greater central government support to address affordability, Wong said.
LAKES WEEKLY BULLETIN Page 17 Trade N Go available now 162 Glenda Drive, Frankton | 442 9926 | lakesmowers.co.nz HOUSE ELECTRICAL for all your electrical needs new builds | renovations | maintenance rob harvey rob@houseelectrical.co.nz 021 115 5637 www.houseelectrical.co.nz Our Services: - Business IT Solutions - Wifi / Network Support - IT Equipment Supplier - Email Domains & Websites - Antivirus & Security Email: support@qttech.nz or ph/text 027 262 3588 Local IT Support
World affairs on the agenda
 By Paul Taylor
By Paul Taylor
A retired NATO commander and an international law expert are among a host of speakers at a security summit in Queenstown next week.

They



It has been organised by leading NZ think tank, the Asia-Pacific Security Innovation Forum and Centre of Excellence.
“Our goal is to bring people together to talk, to come up with solutions to keep the world as stable as possible,” says APSI spokesperson Brett Murphy. “We have some very prestigious speakers lined up, including the second highest ranking US official in NZ, Christopher Allison.
“When you look at the global situation, especially the war in Ukraine, it is as important as ever for democracies to work together to tackle the problems they face.”
Day one focuses on Small States and Partnerships.
Claire Chin will talk about ‘The influence of small states on great powers’, before Dr Siekiera, a Polish lawyer who studied at Victoria University in Wellington, delivers her speech on ‘Small States and the development of international law’.





Retired United States marine LtCol Dave Jonas, now Adjunct Professor of Law at Georgetown and George Washington Law School, will discuss how Taiwan and Japan can deter both North Korea and China, before an open discussion in the afternoon on strategies for small states in the Indo-Pacific. Day two is about Cooperation Among Allies and Partners.
Hagemann, a decorated German army leader and now APSI board member, will talk about the ‘Violation of Alliance Norms: Possible treat and Cooperation’, before Christopher Allison outlines the ‘US policy in the IndoPacific in the Age of Strategic Competition’.
There’ll also be open discussion on how partnerships can address nontraditional security challenges, and breakouts on the Russia-Ukraine War, North Korea and Iran, and human factors in strategy building.
Cultural performances and dinners will bookend the two days of the summit, sponsored by training and research agency ISIFFA International.
It will be held at the Holiday Inn Remarkables Park.


LAKES WEEKLY BULLETIN Page 18 HelpfulAdvice Quick Service Quality Result We also stock an affordable range of giftware, framed prints & baby gear 25 The Mall, Cromwell • Phone 03 445 4595 www.creativeframing@xtra.co.nz WASTE FREE Affordable bulk refills Shop with us for all your bulk pantry essentials of everyday pantry stables, cleaning and bathroom products. e lle locall ith clic an collect. honestwholefoodco.co.nz Talk toour property management superheroes for honest,expert advice and a free market rentalappraisal. Awarded QueenstownChamber of Commerce Small Business of the Year 2021 www.housemart.co.nz Ph: 034423815 Looking for the best return on investment?
Major General Gert-Johannes Hagemann Dr Joanna Siekiera
Major General Gert-Johannes Hagemann and Dr Joanna Siekiera will be joined by more than a dozen experts on international relations and around 20 delegates at the APSI Summit, from December 12-13.
include Deputy Chief of Mission Christopher Allison, from the US embassy in Wellington, and First Secretary of Taiwan to NZ, Claire Chin.
functions Christmas





Now its down to the pointy end with just 3 weeks until Santa comes.











There is still time however to get the steam together for your work Christmas Function.




We’ve got your Christmas functions inspiration right here. These venues have limited availability so don’t delay make you reservation today.




















functions Christmas Christmas is coming! Christmas Gibbston Valley Region/ Arthur’s Point Private Tour Special* CALL TODAY: 0800 6937 2273 | 03 573 5508 ENQUIRIES@HOPONHOPOFFWINETOURS.COM WWW.HOPONHOPOFFWINETOURS.COM *T & C’s: This is our Christmas Private Tour Special. This includes private hire of the bus which is perfect for hens and Christmas parties. The prices are per bus hired. Each bus seats 20pax. Food and wine tastings not included. Book now and mention ‘LWB’ to receive this unbelievable price $ 995 FOR 6.5 HOURS* $ 255 saving HENS PARTY CHRISTMAS PARTY BIRTHDAY PARTY ...ANY PARTY Enquire about our stunning Bannockburn tour, known for it’s exceptional wineries, fruit and history




























































































































































































































































































































































































































































































































































































































































































































































































































































































































































































































































































































































































OPPOSITE THE SKYLINE GONDOLA, BRECON ST QUEENSTOWN | BOOK NOW: ELCAMINOCANTINA.CO.NZ LEGENDARY TEX-MEX FROZEN MARGARITAS GREAT MUSIC FREE SOMBREROS & CHIPS & SALSA THEBAVARIAN QUEENSTOWN BIG FOOD BIG STEINS BIG LOVE OPPOSITE THE SKYLINE GONDOLA, BRECON ST QUEENSTOWN BOOK NOW THEBAVARIANS.COM QUEENSTOWN QUEENSTOWN
Arts+Culture
A Christmas adventure around the Whakatipu
by Jessica Allen
The annual QLDC Christmas show is returning to Queenstown Events Centre this weekend with the 12 Bells of Christmas. The heart-warming story was created by Lisa Clough and Margaret O’Hanlon, with choreography by Anna Stuart – you can expect some laughs, a bit of dancing, traditional carols and familiar locations.

This year’s show will feature an array of local talent including performances by the Remarkable Men’s Ballet, the Wakatipu Children’s Choir, Queenstown Gymnastics Club, Silk and Circus, Wakatipu Conservatoire of Classical Ballet and Dance Evolution Studio. Lisa and the production have long-term relationships with many of the performance groups taking part in this year’s show and will generally reach out to them to get involved. This year they required a different performance, which is when they asked an aerialist to do a special number.
“There’s a lot of moving parts. We audition for our ensemble and our lead roles, who are the singers and the actors. We also audition for dancers and a dance troupe as well, but alongside that we have other performance groups that are teaching and learning, so we pull them in as well, to perform in the show,” says Lisa.
There will be some classic carols to sing along to as well as some modern and fun songs to get your toes tapping. The upbeat story explains Granny’s tradition of collecting 12 bells for Christmas – the children have a mighty task ahead of them. The story focuses on the true meaning of Christmas; family.
“Granny has a special tradition and rhyme about her 12 bells of Christmas. The kids wake up on Christmas Eve to find that the bells and Granny have disappeared, so they go on a rip-roaring adventure around the Whakatipu to find all the bells and solve riddles to find clues. It’s lots of fun. It’s aimed at an audience of two or three years and up, but it’s lots of fun for older kids and adults as well.
“There’s heaps of singing and dancing, and a simple storyline that runs through. It’s only just over an hour long, so it really encourages the whole family to come along – from the little kids to the big kids – and have a really nice day out and get into the Christmas spirit.”
This year the production is also allowing individuals to go online and purchase an additional ticket, which will be gifted to a local family that may not be able to attend. The production wanted to encourage the spirit of giving at this time of year and allow as many people as possible who would like to see the show to have the ability to do so.
The high-energy show also highlights a typical Kiwi Christmas, “it’s really summery, fun and enjoyable, and kids can dance in the aisles. It’s going to be lots of fun,” says Lisa.
Pop on your dancing shoes for the 12 Bells of Christmas, which will take place at Queenstown Events Centre on Sunday 11 December at 1pm and 5pm. You can find out more information and purchase tickets for yourself (or gift one) at christmasshow.co.nz/
ACAS FIRST ARROWTOWN “ART BEFORE DARK” OPEN GALLERY EVENT
The Arrowtown Creative Arts Society is launching the first “Art Before Dark” Arrowtown open gallery event on 14 December from 5:30pm to 7pm.
With a similar format to the popular First Thursday events in Queenstown, this will be a family-friendly opportunity for art enthusiasts to visit seven galleries in Arrowtown, all within a short walking distance of each other. Each gallery will offer visitors a warm welcome and a glass of wine, with a chance to enjoy the art on display in a relaxed way as they learn more about the artists.
ACAS committee member Julian Knights, who helped launch First Thursdays in Queenstown, says Arrowtown offers a very diverse range
of art for visitors and locals alike to enjoy, from some of New Zealand’s leading contemporary galleries, to amazing bronze works, through to the 30x30 show at the Lakes District Museum and Gallery.

“We are delighted to showcase seven amazing galleries in Arrowtown for the enjoyment of art enthusiasts, as well as those who are just keen to learn more. Arrowtown is known for its beautiful scenery and challenging trails, but we also have a very exciting art scene here.”
Popular local restaurant La Rumbla will create a signature cocktail for the event for art visitors to enjoy.
The Galleries taking part are:


• NMG (Nadene Milne Gallery)

• Astor Bristed Gallery
• Fiona Garlick Gallery & Studio

• Birdwoods Gallery
• Bonham Gallery

• The Gallery by Eric Nauta
• Lakes District Museum and Gallery
Artist talks will be held at the following times and galleries:
• 5.45pm at Birdwoods Gallery
• 6.45pm at Fiona Garlick Gallery & Studio
Art Before Dark
Fiona Garlick in her studio. Photography by Angela Tracey
Wednesday
AstorBristedGallery
| BirdwoodsGallery- artisttalk5.45pm| BonhamGallery FionaGarlickGallery&Studio- artisttalk6.45pm LakesDistrictMuseum&Gallery NMG(NadeneMilneGallery) | TheGallerybyEricNauta
December 14th 5.30 - 7pm
The Gallery by Eric Nauta
GOINGS ON ABOUT
EVENTS - MUSIC - ART THEATRE - AT THE GALLERIES

Open Day
Queenstown Windsurf and Kitesurf Club Open day

The Windsurf and Kitesurf Club would love to see locals interested in windsurfing, kiting and foiling at this week’s open day. If you have done a little and want to get back into it or never started but would be keen to learn, come on down catch up with club members who can help answer general questions. If you are new to the area come and to talk to local club members about the best sailing venues and the best weather forecasts to use.
For more info contact Sue on 027 640 8596.
When: Wednesday, 7 December, between 4pm and 8pm Where: Frankton Beach
Art Talk
The Insiders
Broker is holding an artist talk for the opening of its next exhibition The Insiders. The exhibition features 6 artists from New Zealand and Australia and spans photography, video, painting and drawing. Exploring each artist’s contemplation of the internalisation of emotional and psychological states within the external, physical spaces of our existence.
Marc Blake will discuss the background to the processes, concepts and exhibiting artworks with artists Caryline Boreham, Tori Beeche and Ekaterina Dimieva.
When: Wednesday, 7 December, 6pm sharp
Where: Broker Galley, 36 Grant Road, Frankton
Cricket
WHITE FERNS v Bangladesh 3rd T20

The WHITE FERNS play the Bangladesh T20 team at the John Davies Oval on Wednesday in the last of a three game series. It’s not often we get the opportunity to host international cricket games in Queenstown and with a good crowd this week there is always the hope we will welcome a regular schedule of international games. This is the first time under new coach Ben Sawyer, the WHITE FERNS have been playing at home.
Tickets at tickets www.nzc.nz
When: Wednesday, 7 December, 2pm – 5pm
Where: John Davies Oval – Queenstown Events Centre, Joe O’Connell Drive, Frankton
Jewellery Design Show
Vu Jewellers are holding a jewellery design show in their store on Thursday to support talented individual jewellers from across New Zealand. All the jewellery is new to the store and timed for the Christmas trading period. It’s a relaxed evening with wine and nibbles.

When: Thursday, 8 December, from 5pm to 8pm
Where: Vu Jewellers, 5 Hawthorne Drive, Frankton
If you would like your show, event, exhibition or meeting promoted in Goings On drop me a line at davidgibbs@qmg.co.nz with the details.
Fundraiser
Liger Leadership Academy Fundraising Soireé
This is the Liger Leadership Academy students 1st Fundraising Soirée with an evening of classical music, wine, canapes and silent and live auctions to raise funds for NZ students to travel to academy in Cambodia.
The evening features world renowned musicians Kate Targett-Adams and Kinga Krupa.
Tickets at Eventbrite.co.nz or email fundraising@ligeracademy.org.nz for more information.
When: Friday, 9 December, 6pm Where: Thomas Brown Gallery, 568 Speargrass Flat Road

Christmas Fundraiser
Santa’s Grotto at Minus5 Bar
The 12th Annual Santa’s Grotto is a very special opportunity for the family to visit Santa in his natural frozen environment, just like the North Pole where he and his reindeers live.
For a donation of $5/child or $10/family, watch the kids light up at the sight of Santa, they’ll also get the opportunity to have a chat and pose for a photo with the man in red himself. There will also be face painting and colouring available. This is a firm family favorite fundraiser 100% of proceeds going to Wakatipu Plunket.
No bookings required, just come early.
When: Saturday, 10 and Sunday, 11 December, from 10am to 2pm Where: Minus 5º Ice Bar on Steamer Wharf

Christmas Show
12 Bells of Christmas

When Granny shares the family tradition of collecting 12 bells for Christmas, the children have one mighty task ahead of them in this timeless story of the true meaning of Christmas; family.
Once again Lisa Clough and Margaret O’Hanlon have created a heart-warming, magical and fun story backdrop with stunning choreography by Anna Stuart, incorporating popular songs and traditional carols, and a few surprises along the way.
Tickets are at Eventbrite.
When: Sunday, 11 December, 1pm and second show at 5pm Where: Queenstown Events Centre, Joe O’connell Drive
Candlelight Evening Christmas Candlelight Evening - Compassionate Friends
Compassionate Friends are inviting parents, siblings, grandparents of bereaved children and their families to a Christmas Candlelight Evening. Attendees are invited to bring a photograph or portrait painting of your loved one as well as a candle. Supper will be provided. Any enquires phone Pauline, Central Otago Co-ordinator on 0273 960 611.
When: Monday, 12 December, between 7pm and 9pm Where: Alexandra Community House, 14/20 Centennial Avenue, Alexandra

Exhibitions
Arrowtown “Art Before Dark”
Arrowtown Creative Arts Society is behind the first “Art Before Dark” Arrowtown open gallery event being held next week. This is a similar format to the popular First Thursday events in Queenstown and is a familyfriendly opportunity for art enthusiasts and locals to visit seven galleries in Arrowtown, all within a short walking distance of each other.
Each gallery offers a warm welcome and a glass of wine, with a chance to enjoy the art on display in a relaxed way as they learn more about the artists. See Arts and Culture for more.

When: Wednesday, 14 December, from 5:30pm to 7pm
Holiday Programme
Te Atamira Summer Holiday Programme

Te Atamira Summer Holiday Programme creates a fun environment for kids to get creative. The programme is led by accredited art teachers with each workshop enhancing the participants creativity and imagination. The programme is designed for children aged 5-12. More information is available at teatimira.nz/whatson
When: Monday 19 to Thursday 22 December, from 9am to 3.30pm

Where: Te Atamira, Dart House, Remarkables Park Town Centre, Frankton
Gardening
Native Plant Nursery Volunteer Sessions
The Whakatipu Reforestation Trust’s restores the biodiversity of the Whakatipu Basin through revegetation projects, education, collaboration & advocacy. The community nursery is where all the native plants for community planting days are grown.

Volunteering at the community native plant nursery provides an opportunity to make a difference, learn new skills and meet a range of interesting people.
The weekly sessions are open to everyone. No experience is needed and a coordinator will assist all volunteers. It’s drop in style, with morning tea provided.


When: Every Wednesday morning until 21 December, between 9am-12 noon
Where: Jean Malpas Community Nursery, Jardine Park, Kelvin Heights
Exhibition
SHELF-LIFE
Te Atamira’s first international exhibition opened on Monday 5 December. SHELF-LIFE is series of photographs by international award-winning British artist Mandy Barker highlighting the impact of society’s reliance on plastic and the damage it causes to marine life and, ultimately, ourselves.

When: now until Tuesday, 24 January 2023


Where: Te Atamira, Dart House, Remarkables Park Town Centre, Frankton

LAKES WEEKLY BULLETIN Page 25








1876 HOSPOGUIDE OPEN FROM 4PM DAILY $8 TAP BEER ALL DAY EVERY DAY!! OPEN FROM 11AM - 7 DAYS A WEEK! OPEN EVERYDAY FROM 12PM WITH 22 TVS PLAYING SPORT! BIG APPETITE AND FAMILIES WELCOME! Wednesday FREE Pizza Night Sunday Karaoke from 9pm – 1am with FREE spicy chicken wings from 8pm-12am. FREE Pool and Shuffle Board Game. FREE Bull Riding. Or just relax and enjoy a night out at Cowboys. Wednesday John Healy live from 9pm! Thursday Danny Atkinson live from 9pm! Friday John and Jamie live from 9pm! Saturday Treble Trouble live from 9pm! Sunday Sunday Roast Served all Day! Sunday trad session from 5pm! Wednesday Ladies night $10 pornstar martini’s Brett Walker Tuesday $10 Food specials every day Thursday DJ Mo Friday DJ Ribera Saturday DJ Jah Fire Every Day from 3pm-8pm Free Bar Snacks Tuesday Hospo night DJ MAD Drink Specials all night Tuesday $12 Classic Pizzas Thursday $7 Pints Wednesday Open Mic Night from 9.30pm Wednesday Doubles Pool Comp Monday Free Chicken Wings* *T’s & C’s apply Monday Singles Pool Comp Thursday TJ live from 9:30pm Saturday Live Sports Saturday Live Music w/ Jack Summersides Friday Live music from 9.30pm Sunday Live UFC Saturday DJ MAD from 9.30pm Sunday DJ MAD from 9.30pm Sunday UFC 2pm Jasse Gama 3pm DJ Ribera 6pm $10 FOOD SPECIALS, $6 HOUSE BEERS, WINES & SPIRITS ALL DAY EVERY DAY!! Every day Try our Bavarian Fest! 2 hours beverage package & all-youcan-eat meat $89 Wednesday All-You-CanMeat! Every day Happy hour 4-6pm MON-FRI Oktoberfest Saturdays $35 Oktoberfest Package! Dirndls, games and steins! Christmas Eve 3 course BBQ dinner 14 Dec $49 per adult, $25 child Seattings at 5.30 & 7.30pm. To book email info@lokalqt.co.nz or ring us 03 442 5444 Happy Hour from 4pm – 7pm, with drinks from $7 Available WednesdaySunday Thursday 20% off pizzas Dine in or takeaway Thursday 2 for 1 Woodfired Pizzas Wednesday $37 Export Gold Towers (minimum 3 people) Happy Hour 8-10pm $7 Spirits, $7 Wines, $7 Beer & $18 Cocktails Wednesday, Thursday, Friday, Saturday & Sunday Nightly House DJ’s from 8pm-4am Saturday Signature Cocktail Specials Fri, Sat & Sun Happy hour 4pm-6pm on selected tap beers, wines and spirits Friday $18 Double cheeseburger, fries & a house drink Sunday Sunday only BBQ platter Special $28 per person on Chef’s selection of BBQ meats, sides and sauces 12pm till close or sold out Bookings are highly recommended! Monday and Tuesday CLOSED Open 4pm - 8:30pm WednesdaySunday 47 Camp Street misslucys.co.nz HAPPY HOUR FROM 4-6PM EVERY DAY! $12 MARGARITAS AND BEERS FROM $7 Wing Wednesday 20c wings Thursday 1/2 price fajitas Taco Tuesday $3 tacos Mad Monday $5 tacos & $1 wings























LIVE MUSIC DJ’S SPORTS BAR SPECIALS EVENTS OPEN EVERYDAY FROM 5PM! ALL SPORTS. ALL DAY. LIVE & LOUD | OPEN FROM 12PM | FOLLOW US ON FB + INSTA FOR ALL UPCOMING SPORTING EVENTS Friday DJ JT 10-4am Thursday DJ Zahn 10-4am Saturday DJ Foz 10-4am Sunday DJ Charlie 10-4am 13 Taps of local and NZ craft beer and cider! $2 TACOS (with any beverage purchase) Every Tuesday 3pm-9pm Friday FIFA World Cup Live Calico, 5pm Friday Bangers with DJ Tessa 9pm HAPPY HOUR 3-5pm EVERY DAY! $9 Whakatipu Brewing pints & $9 house wines! Wednesday Silent Disco 9.30pm Three Colours, Three Channels, Three Djs Live sky sports every day! Thursday Open Mic Night 9pm Bring your mates, play whatever! Wednesday FIFA World Cup Live, 8am Comedy Open Mic, 8pm Wednesday WING IT WEDNESDAYS HALF OFF WINGS ALL DAY FIFA WORLD CUP 8AM MATCHES MONDAY & SUNDAY!! HAPPY HOUR WEEKDAYS 4-6PM SUNDAY UFC 282 Błachowicz vs. Ankalaev CAESAR SUNDAYS $2 OFF ALL DAY LONG 6 NOVEMBER- 12 DECEMBER Full menu available WednesdaySunday 12pm-8pm Saturday FIFA World Cup Live, 8am Warped Tour Queenstown: Silkworm preform Enema of The State and More, Free Gig Sunday FIFA World Cup Live, 8am Saturday CC Disco 3pm Sunday Sunday Sessions The The Bunker DINE ● WINE ● COCKTAILS ● LATE NIGHT COW LANE, QUEENSTOWN Est. 1997 Find us @ILLABB, 30 Shotover Street 7am – 3pm DAILY | @dropcafeqt Locally roasted coffee QUEENSTOWN'S NEWEST CAFÉ “the best toasties in town” – from several customers FREE VENUE HIRE T&Cs apply, contact us on 03 442 9995 or email queenstown@lonestar.co.nz to plan your next function. T&Cs apply, contact us on 03 442 9995 or email queenstown@lonestar.co.nz to plan your next function. OPEN 7 DAYS: 9am - Late Corner Tex Smith Lane & Hawthorne Drive, Frankton www.superliquor.co.nz | 03 442 9801 | info@slremarkables.co.nz Remarkables Park The bottle store with something more SEND A PHOTO OF YOU WITH THE LWB AROUND NZ to graphics@qmg.co.nz and be in to win a Devil Burger Meal Voucher DID THIS AD GET YOUR ATTENTION? THAT IS THE POWER OF BUSINESS LINE ADS Contact the Lakes Weekly Bulletin today on 03 409 2800 or email enquiries@qmg.co.nz
Queenstown-based business wins at Deloitte Fast 50 Business Awards
Element Raw Materials, traders of new technology, more e cient and e ective chemicals, fertilisers and polymers, have won two awards at this year’s Deloitte Fast 50 Business Awards.

e Queenstown-based company took out the Fastest Growing Retail and Consumer Products Business, and also snagged a spot on the prestigious Fast 50 index, placing 33rd with 221% revenue growth year-on-year.
e Fast 50 index was launched in 2001 and recognises New Zealand businesses that have shown signi cant growth over the past three years based o their revenue growth percentage. Criteria for the businesses includes being a New Zealand registered business trading for a minimum of three years and having a revenue of $1m or above in FY20. e businesses must have also submitted independently prepared nancial statements for FY20 and FY22, and supplied export revenue for those two years.
Element Raw Materials was formed in 2010 and recently shi ed their business to Queenstown with warehousing operations in Auckland.
Technical Director Jason Reid created the company a er 12 years of successful chemicals trading for corporates. ey now work with businesses all over the world including Australia, Taiwan, Korea, China, and Europe.
“We can run our business from anywhere. I’ve spent quite a bit of time down here, enjoying doing things in Queenstown, and we just wanted to move down here and run our business. It’s just
by Jessica Allen
a beautiful place to be – I’ve got lots of hobbies down here. Our children have all le the house, so we thought we’d move down and nd some beautiful scenery. It’s a great inspirational place to work from,” says Jason.
e business runs with a slightly di erent structure. ey don’t need a lot of sta and count some of the largest companies in the world as both customers and suppliers including Bayer, BASF, Solvay, Dow and Sinochem. Selling the latest breakthrough technology samples, creating brand value, leading technology, and environmental bene ts for their diverse customer base is their focus.
“Other companies in our industry have large o ces, warehouses and lots of sta , whereas we use our virtual systems and third-party logistics partners in cloud-based systems, so we don’t really need many sta . So there are a couple of us in the o ce, and then we use all our virtual systems and partners for all of the other followup work.”
Of the two awards, it was a highlight for Jason and the Element Raw Materials team to win the Fastest Growing Retail and Consumer Products Business award in the Otago region. “It’s nice that we’ve moved down to Otago and have won that regional award.” Jason also appreciates the recognition of the long development process of building the company, especially given the challenges businesses have had to face over the past three years. e company has developed and evolved in its 13 years of operation, but Covid has seen them adapt more than ever.
“Covid has been good for us because we have a clear strategy to have closer sourcing and strong logistics. We have some new-generational, or newer sourcing than a lot of traditional longerterm companies have used in New Zealand. Over Covid, those suppliers that are o en based in Europe and the US have had huge supply and manufacturing issues. ose changes have really helped us to grow the business and gain market penetration.
“ e recognition of the Deloitte Fast 50 is really fantastic for our business because it gives us some independent recognition, not just by our customers but also by our logistics partners and new developing companies that we’re looking to gain a foothold into, as well as to our suppliers. Our suppliers are overseas and don’t know a lot about New Zealand or who we are, apart from when I’ve met with them and been over there or through correspondence with them. So being able to see that award recognition has been quite valuable to us for the suppliers,” says Jason.
Fellow Queenstown business Remarkable People also took out the 41st spot on this year’s index a er losing 90% of their turnover overnight when businesses shut down due to Covid-19. e fullservice recruitment agency pivoted and opened up new areas to bring new clients on board, which has resulted in them placing between 700 and 1000 people per week, and 173% revenue growth year-on-year. Over the hill in Wānaka, Stoked Stainless, who create cedar hot tubs, ranked tenth on the index with 374% revenue growth.
QT BUSINESS December 2022
Jason Reid and Katherine Wilson
Top award for Queenstown hotel
New Zealand’s rst ‘beyond ve star’ hotel, e Carlin in Queenstown, has earned more accolades to its name, winning a prestigious international industry award.

Earlier this month e Carlin was crowned as the Best New Hotel in Australasia, Best Hotel With a View: Australasia and the World’s Best New Hotel at the 2022 World Boutique Hotel Awards.

And the luxury hotel was also recognised by the Hotel Management Awards as a nalist in the Best New Zealand Hotel category. is Awards ceremony took place in Sydney last Friday night. e 12th annual Boutique Hotel Awards is an independent awards organisation, where every property is visited by an experienced hotel judge.
“Finer details – beautiful teal leather umbrellas, choice of pillows, mood lighting chau eur service and the exceptional 24-hour on-call sta make newcomer e Carlin Boutique Hotel truly stand out. We con dently expect to see e Carlin taking more awards in the future,” judging notes say. Winners were selected from more than 250 nominees in 70-plus countries. Judges document all aspects of the guest experience, covering elements of dining, design, concept, facilities, location, service and emotional impact.
e Carlin’s latest accolades come seven months a er opening its doors, when New Zealand borders re-opened. Earlier this year, e Carlin was mentioned in TIME’s World’s Greatest Places, which highlights 50 extraordinary travel destinations around the world. e Carlin was
featured as one of the exciting new hotel openings in Queenstown, as Queenstown itself earned a spot on this year’s list).
e Carlin founder and majority shareholder Kevin Carlin says he is thrilled with the international success that the boutique hotel has achieved, in just a short amount of time.
“It’s very humbling for e Carlin to receive this sort of international recognition,” Carlin says. “We pride ourselves on delivering an outstanding level of service, and these awards formally acknowledge the hard work of our team.
“Bookings and enquiry have been increasing over the past seven months and we are preparing ourselves for a busy summer season, with visitors from all over the world booking to stay at e Carlin.”
New courses target diversification
SIT Queenstown campus plans to become a key part of the resort’s move to diversify its economy. Pre-Covid, the Southern Institute of Technology had a high proportion of international students studying Hotel Management, Cookery, Travel and Tourism, with the graduates then employed in local industry.
But with international students unlikely to return quickly, or in the same numbers, there has been a shi in the educational focus to draw domestic students locally and nationally.
New courses include Environmental Management, which was rolled out earlier this year, along with Applied Management, Audio Production and Creative Arts options.
IT Programmes are also expanding, with So ware Development, Programming and Cyber Security being added in 2023.
Campus development manager Nick Fi eld says those interested in study should commit now. If the programmes are to be successful, there needs to be demand.
is is where “the rubber hits the road” around the talk of economic diversi cation, he says.
“Unless we commit to changing how we view education as a tool for retaining and attracting talent and get behind it, it won’t happen.
“Queenstown is at a tipping point population wise - there is demand for many di erent programmes, but not always the numbers to get opportunities o the ground and sustain them all.”
SIT Queenstown Campus was established in 2009 and became part of Te Pukenga, e New Zealand Institute of Skills and Technology in November. It will continue to o er the applied training in cookery, hospitality, beauty therapy, and carpentry.

QT BUSINESS December 2022
The Carlin, Queenstown
Kevin Carlin and Small Luxury Hotels of the World plaque
SIT Queenstown Campus development manager Nick Fifield
Water the garden
The elixir of life is often overlooked when we think about growing veggies.

Water water, there seems to be plenty coming out of the skies this spring yet as we all know suddenly and usually the tap gets turned off for the summer. In other parts of the country watering the garden can be an afterthought, for us living in the rain shadow of the southern alps it can blow for days with the promise of rain only for the front to spit a few drops and then head up the west or east coasts.
An ideal climate would be a couple of nice rainy days a week, better still rainy nights.
This lack of rain might not be so bad if it wasn’t so windy!! The wind just strips our soils of moisture so that we’re always in a moisture deficit. Ideally we are going to water our gardens from above imitating nature. Walking around with your garden hose can become time consuming. A simple oscillating sprinkler that goes back and forth is perfect and relatively inexpensive. Pop a timer on it and you don’t have to remember when to turn it on and more importantly when to turn off.
As our garden gets bigger so do your watering needs. Efficiency of delivery becomes more important as more and more of our homes are metered.
Top water tips
1. A long deep water every other day is more beneficial than daily short watering. Your plants roots grow where there’s water. Shallow watering encourages shallow roots. This leads to less resilient plants in times of stress or your water system breaking down. So watering for longer to get water and roots to go deeper.
2. Mulch (straw/leaves/wood chips...) as well as feeding your biology and plants in the soil etc Mulch stops and slows the evaporation of water from your soil. It also prevents soil compaction that rainfall and your sprinkler system causes on the soil surface.
3. The more organic matter in our soil the greater the water holding capacity it has. Generally we all have sandy and silty soils, that have very poor water holding capacity. So we need to really focus on getting our organic matter levels up. Think regular applications of compost, vermicast, leaf mould and mulch. Products like biochar increase the water holding capacity of the soil too.
4. When do we water? Watering in the morning, gives plants a chance to get through a hot or windy day with less stress.

I’ve tried lots of leaky hose systems over the years with varying success. Changing to an overhead system I experienced major improvements in my growing of veggies. By overhead I mean a series of sprinklers attached to some Waratahs banged in the ground placed in the corners to ensure good coverage. Simple and efficient at getting the job done. Simple it may be and yes very efficient at getting the water out, but I’m still watering my pathways needlessly. A more efficient delivery can be sprinklers for each bed. As crops get bigger these can be less efficient at delivery as the plants get in the way..
I haven’t found the perfect system overhead delivery system but I’m loving this one... Let me know if you have found it.
In my tunnel house I have 2 systems in play. The overhead sprinklers run for most of the year. I grow a lot of tomatoes and they don’t like too much water from above as they move into fruit ripening. Overhead watering can encourage humid disease loving conditions. As the summer season goes along I switch to inline drippers on the beds. Giving the tunnel house an overhead water once a week.
5. How long do I water for? We mentioned longer is better. So think 30minutes rather than 10 minutes. Get in your garden after you’ve watered and dig a hole. How deep did your water go. 2cm or 10cm? 10 plus is preferable. Dig a few holes you might find the sprinkler system delivers more water to some areas of the garden. You could then plant accordingly with water hungrier plants in those areas. Eg pumpkins, zucchini’s, tomatoes, celery, cucumber and corn...
6. Capturing rainfall. Consider wood chipped pathways 20-30cm deep to capture and soak water into your landscape.
7. Planting comfrey down stream from your veggie garden can be used to capture any soluble nutrients and excess watering that might occur with rain events.

8. Consider capturing and storing your roof water. There are simple tap into downpipe systems available.
9. On town water? Chlorine is not the gardeners friend. Putting water in barrels and totes is a way of allowing the chlorine to gas off. Agitating the water with a cheap fish tank aerator will speed up the process.
10.Ever noticed your plants are glowing after a rainfall. Rain is best capturing nitrogen on its way down giving our plants a feed.
Dr Compost aka Ben Elms is a permaculture and gardening expert who’s been operating in the unusual Central Otago climate for over 20 years. Funded by QLDC and delivered by Wanaka Wastebusters, the Dr Compost project aims to reduce organic waste going to landfill. Got a question? Check out @drcompost on Facebook or benelms.com @dr_compost | @doctorcompost | benelms.com














Join aninternationalteamona mission tobring realfun tolife. skyline.co.nz/careers See our jobs: Join us and deliver real fun to the world. We’re looking for: PhotoSales Food & Beverage Attendants Guest Service Host Gondola Operator Luge Operator Walking Guide Accounts Administrator Come for a season, Stay for the fun! BarAttendants Commis Chefs Chef de Partie Cleaners Cleaning Supervisor Retail Assistant If this sounds like you, jointhe fun and workwhere othersholiday! Whetheryou are a long-time local, arecent graduate or in town for a season, we’re o ering development and opportunity in a stunning location. Plus, you'll enjoy gondola and luge rides for family and friends, complimentary sta meals, a minimum of 30 hours and a great work life balance.













Page 32 Ph: 03 409 2800 info@qmg.co.nz o fi .co.n VACANCIES LAKES WEEKLY BULLETIN | th ecem er th ecem er Chef Columbus Coffee, Frankton in Mega Mitre 10 We are looking for a Chef to join our team • No split shifts • Day time hours – home by 3pm • Competitive hourly rate • Fantastic working environment • Guaranteed hours for 16 to 30; more available if wanted • Experience: entry level and beyond Please call owners on the mobile numbers below: Johnny Oaten & Alex McMillan Owner / Operator T 03 441 4432 | M 027 637 3304 | M 027 230 9964 columbuscoffee.co.nz Advertise your job vacancy Upload online at jobfix.co.nz
COME AND WORK WITH OUR FRONT OF HOUSE TEAM AT BLUEKANU RESTAURANT & BAR, QUEENSTOWN!!

We are a fun, energetic award-winning team who are all striving for the same results – great atmosphere, lots of laughs, good vibes, delivering amazing cocktails and food!
Available Roles Full-time and Part-time:
•
BAR MANAGER / BARPERSON
•
FRONT OF HOUSE SERVER

What’s in it for you:
- Market leading rate for the right person
- No split shi s
- Fantastic team environment
- Guaranteed hours
- Sta perks
- Training & Management support provided
What we are looking for:
- Good people skills
- Good knowledge of food & beverage

- Can make a good cocktail or three
If you’re looking to take your next step forward with a thriving restaurant, please get in touch! Check out our website at www.bluekanu.co.nz and send your info through to Wazza (General Manager)Warren.ratana@gmail.com
Infinite Energy is a locally owned and operated company that designs and installs solar energy solutions. Based out of our Cromwell branch, we are seeking to employ at least two new solar installers and an electrical apprentice for our rapidly growing business. You’ll be working on some of the most significant solar power & electrical projects in the region, plus working on a range of grid connected, hybrid, commercial and o -grid solar installations. No experience necessary as there will be full on the job training.
Solar Installer
The successful applicants must have
•Strong customer focus and communication skills
•Highly disciplined and able to follow instructions
•Have a full NZ driving License.
•A can-do attitude, willing to work in all outside weather conditions to complete the job
•Willing to take on new challenges
•Flexible, willing to work overtime and occasionally travel away from home for work
•Honest, reliable and punctual
In return we can o er
•A competitive remuneration package based on experience
•Career progression and training
•Excellent team environment
•Varied and interesting work
Electrical Apprentice
•The successful applicant must have
•Strong customer focus and communication skills
•Highly disciplined and able to follow instructions
•Have a full NZ driving License.
•A can-do attitude, willing to work in all outside • weather conditions to complete the job
•Willing to take on new challenges
Supporting everyone towards better health
Do you want a job where you know you are contributing to your community?
Accounts Receivable Assistant

We are on the lookout for an Accounts eceivable Assistant for a xed term position for the next 6 months
We can offer:
• Flexible workdays and hours

•Full training
• Great work perks
• And a supportive team Experience using ero is advantageous ou must be eligible to work in New ealand to be considered for this opportunity
For further information or to apply, email hr@qmc.co.nz

Flexible, willing to work overtime and occasionally travel away from home for work
•Honest, reliable and punctual
In return we can o er
•A competitive remuneration package based on experience
•A full Electrical Apprenticeship
•Excellent team environment
•Varied and interesting work
•Ongoing training
These roles are immediately available, please email an application, CV and references to:
Marco Frediks
email: marco@infiniteenergy.co.nz
Applications close Wednesday 21st December 2022. www.infiniteenergy.co.nz
LAKES WEEKLY BULLETIN | 6th December 2022 - 12th December 2022 SITUATIONS VACANT Ph: 03 409 2800 | info@qmg.co.nz | jobfix.co.nz Page 33
Need someone now? There are currently over 300 willing jobseekers ready to work in the Queenstown area. Go to jobfix.co.nz
ff n e
The Lodge Bar Queenstown is looking for an outstanding individual to join our team!

Attitude to learn is essential.
aving previous bar and ne dining experience preferred Cocktail, wine, beer and spirit knowledge a plus.
Ideally looking for a 6-month commitment. Small team, gorgeous views, fantastic bene ts and great operating hours Full time positions available.
Contact is Christine at christinea@roddandgunn.com
McDonald’s Restaurants Queenstown are looking for full time & part time staff for our restaurants in Frankton and Camp Street for the positions of:

•BARISTA
•LATE NIGHT STAFF (kitchen or service)
$25 an hour – Sponsorship Available. We are Accredited with Job Tokens ready to go. Daytime Kitchen, Service, & Cleaning roles also available.
To apply, please send your CV to: hr.mcds.qtown@gmail.com or scan the QR code and apply online

os l ff n e
Red Rock is seeking motivated individuals to join our small team for spring and summer due to some long serving staff moving onto pastures new We are looking to ll the following positions with immediate starts available:
•Baristas
& Bartenders
•Breakfast Cook / Chef
•Cook
•Duty
/ Chef
Manager
Full time and part time, and casual positions are available. Competitive hourly rates based on experience. You must have the right to work in NZ or hold a current working holiday visa. If you have experience in any of the above positions or are looking to learn, please forward your CV to bcb@outlook.co.nz or come into 48 Camp Street and speak with a manager.



Supporting everyone towards better health
Seeking early birds and night owls
Queenstown Medical Centre is looking for a part-time cleaner to keep our premises pristine and squeaky clean.

Role involves general cleaning duties to a high standard, nothing too icky.
Opportunities in Queenstown, Frankton, Jacks Point and Arrowtown. Choose your own hours, either morning or evening.
Full training and equipment provided.
Access to great work perks!
Please only apply if you have the right to legally work in New Zealand.
If you want to be part of the Queenstown Medical Centre Team, please email hr@qmc.co.nz

Housekeepers Wanted
•Self motivated, able to work alone
• E cient, able to work under pressure
•Experience preferred but not essential
• taff re uired immediately and for busy summer period
• We are accredited employer & can offer visa sponsorship

•$26-$28 per hour depending on experience
Email your CV to operations@staysouth.com
Cafe Society is looking for Barista / Cafe Worker, Chef & Chef de Partie

Come to join the cafe society team. Day shift only hours, great pay in the modern cafe.
Send us your CV and a cover letter at: societymanager@xtra.co.nz
We look forward to hearing from you.
LAKES WEEKLY BULLETIN | 6th December 2022 - 12th December 2022 SITUATIONS VACANT Ph: 03 409 2800 | info@qmg.co.nz | jobfix.co.nz Page 34
your
Advertise
job vacancy jobfix.co.nz
Chef de Partie Kitchen Porter



Joinery Foreman

CSR position
Rad Car Hire Queenstown are searching for a new CSR. As a CSR you will be responsible for providing a seamless customer experience, vehicle grooming, shuttle operator, o ce systems & check out/in of customers.



We’re looking for someone who is focused on Customer ervice & able to work in a small team.




Part time and full time available. Please send CV’s to both queenstown@radcarhire.co.nz & hamish@radcarhire.co.nz
CAFE CHEF BAKER BARISTA
KITCHEN HAND
LAKES WEEKLY BULLETIN | 6th December 2022 - 12th December 2022 SITUATIONS VACANT Ph: 03 409 2800 | info@qmg.co.nz | jobfix.co.nz Page 35 Contract building crews wanted for ongoing residential projects. Great conditions and rates, Immediate work available.
Steve 027 530 7017
Call
Must
or valid work visa.
cabinetry
timber
ASSISTANT For a large, busy gift and souvenir shop in Arrowtown. You must: •Have great costumer service •A fantastic work ethic •Can work weekends Please phone
480 8804 or email thegoldnuggetarrowtown@gmail.com
Queenstown’s home of house music is looking for: Duty Managers Bartenders •Competitive Pay • taff Perks •Part time/full time hours available Please email or Andy via email or phone: 022 406 1707 Andrew.moore@goodgroup.co.nz REQUIRED NOW!!!!!!
and Unskilled
Looking for casual, temporary or long term work??
Personnel and Labour Hire are looking for labourers for a variety of jobs around Queenstown with an immediate start. Contact Sharleen - 027 778 7377 or email sharleen@qtplabour.co.nz
Wanted •
have NZ residency
• Must be trade uali ed in
and
joinery. • Must have minimum year’s experience in a similar position. •Must hold current full drivers licence •This is a full-time role. • Remuneration by negotiation is relevant to experience. To apply please email your CV to: queenstown.joinery@xtra.co.nz RETAIL
Lara 027
Is currently seeking CHEFS / LINE COOKS Min$25per hrs more based experience If you're interested in joining one of Queenstown's iconic restaurants and bars email your CV to chris@smithscraftbeer.co.nz or apply in person. Valid working visa required.
Skilled
Labourers
Queenstown
committed and reliable professionals to join our busy kitchen in preparation for the
time of the year.
these roles
We are now looking for staff for the busy summer season. No nights, exible, stable rosters and
great team are
of the package! Positions available
Seeking
busiest
If you have Full Time availability and any of
are of your interest, please apply sending your cover letter and CV to warwick.taylor@goodgroup.co.nz
a
all part
for:
Experience necessary for the positions. Must hold a valid visa. Pop in and see us or email your CV manager@theexchange.kiwi
Night Shift Commercial Cleaner
Time, set chedule, same days off every week, Excellent pay!
us and we can talk hour$
Full
Full training provided, just a can-do attitude required! Email: riseandshinenz@gmail.com Phone: 021 241 8788 Contact
s ff oo unne s
Sous Chef Chef de Partie














les onsul n
LAKES WEEKLY BULLETIN | 6th December 2022 - 12th December 2022 SITUATIONS VACANT Ph: 03 409 2800 | info@qmg.co.nz | jobfix.co.nz Page 36
Queenstown's home of Sport and Pool is looking for: Part time or Full time bartenders •Starting rates of $23+ • taff Perks • Early nishes •Fun team Please email or Andy via email or phone: 022 406 1707 Andrew.moore@goodgroup.co.nz
Bartenders •Full time, part time or casual •$24+ per hour •Great tips • taff perks
Please email Nicole via Nicole.simister@botswanabutchery.co.nz ull me me o c su l bartenders
•Previous cocktail experience preferred •Competitive pay • taff Perks •$25+ per hour
Please email Nicole via Nicole.simister@botswanabutchery.co.nz
committed and reliable professionals to join our busy kitchen in preparation for the busiest time of the year.
apply sending your cover letter and CV
u u
are looking for a friendly salesperson to join our passionate team at our pearl jewellery store
will
on
shifts that include late nights
We offer
higher
Applicants must have a valid work visa. Luxury sales experience preferred but not essential. le se nclu e co e le e n o Info@laperle.co.nz AIRPORT CAFÉs Come join our fun team and work in an exciting airport environment! PERKS OF WORKING FOR US: •Discounted accommodation within walking distance •Daily sta meals •Competitive wage •Flexible roster to spend more time exploring Queenstown •Free co ee all day everyday •Professional career path •Relocating support THE FOLLOWING ROLES ARE AVAILABLE: • Cafe Manager • Barista • Duty Manager • Grill Chef We have full-time, part-time, and seasonal positions available. APPLY NOW Scan QR or email justin@airspresso.co.nz ome n o n ou un e m o le n n n en nce n u l on ol experts! •Full and part time positions available! •Management position available •Great pay rates •Awesome team •Work Life balance •Training and transport provided •Accredited Employer Email sl o es m l.com ull me esse ole at Frankton Hair Studio Apply Now. We're looking for a full time hairdresser for our amazing team here at Frankton Hair. Hours are negotiable Monday to Friday with one late night but NO weekends required! We’d love you to have a few years experience and be competent in all aspects of Hairdressing. Start date negotiable.
this sounds like you, call Becky on 021 144 8191 or email your C.V to n on m l.com
Kitchen Porter Seeking
Please
to warwick.taylor@goodgroup.co.nz
We
in Queenstown. You
work
rostered
and weekends
a much
than New Zealand Living wages and plus the monthly bonus.
If
Cafe / Restaurant Assistant required in Glenorchy. 2 per hour Minimum of 30hrs per week Return travel from queenstown included. Previous experience preferred but not essential. queeniesdumplings@gmail.com

AVIS & Budget Queenstown

RENTAL SALES AGENT


Do you enjoy working in a fast paced environment where the days go quickly?

Do you enjoy meeting and talking to people from all over the world?
Do you appreciate a consistent working roster because your life outside of work is important too?
If you answered yes to any of these then maybe this customer service, sales and office administration based role is the new job for you.
Full Time & Part Time contracts available with set days off, Shifts are mostly 8am to 5.30pm with at least one evening shift per week. The role also requires you to work weekends or at least one weekend day per week. You'd be based out of our Queenstown Airport office in Frankton.





What you need: •Full drivers licence • Good command of the English language •Working rights in New Zealand Please send a CV to: luke.dennington@abgroup.co.nz

Shape Your Future With Us
Queenstown Pharmacy is looking for a parttime website assistant for our website, Allergy Pharmacy.


No previous website experience is needed. ours are exible but ideally between 9am 2pm each weekday
The role would include packing and sending orders, and some customer service by phone/ email.
Contact: lydia.qapl@gmail.com
LAKES WEEKLY BULLETIN | 6th December 2022 - 12th December 2022 SITUATIONS VACANT Ph: 03 409 2800 | info@qmg.co.nz | jobfix.co.nz Page 37 SALES ASSISTANT FIXED TERM FULL TIME: DECEMBER 2022-APRIL 2023 The Kiwi Park is a family-owned 5-acre wildlife sanctuary in beautiful Queenstown, displaying over 20 species of native NZ birds and reptiles as part of nationally managed programmes. Conservation is our passion. We are looking for a Sales assistant / guest services superstar, someone who is passionate about wildlife and conservation, has excellent communication skills and great customer service. Requirements • Experience in a customer service role • Basic computer literacy, an understanding of email, Microsoft programs and basic computer skills • Excellent speaking and communication skills and the ability to engage well with visitors • Weekend availability required • Barista training is desired but not required • You must have the legal right to work in New Zealand to be considered for this role Send your CV + cover letter to gemma@kiwibird.co.nz HOUSEKEEPING SUPERVISOR –COPTHORNE LAKEVIEW FRONT OFFICE Duty Manager, Receptionist, Porter, Reservations FOOD & BEVERAGE F&B Attendants, Kitchen Attendants CHEFS Sous, Apprentice Chef HOUSEKEEPING & LAUNDRY Room Attendants, Laundry Attendants
We have incredible opportunities in a variety of roles with shifts and hours that will suit whatever you are looking for across our Queenstown properties. Housekeeper / Commercial Cleaner We require a cleaner to join our team. We are looking for a reliable and enthusiastic team player with great attention to detail. Offering 2 30 per hour Please apply by forwarding your CV to stay@alexisqueenstown.co.nz
Advertise your job vacancy Upload online at jobfix.co.nz FOR YOUR JOB VACANCY FIND THE PERFECT CANDIDATE


















LAKES WEEKLY BULLETIN | 6th December 2022 - 12th December 2022 SITUATIONS VACANT Ph: 03 409 2800 | info@qmg.co.nz | jobfix.co.nz Page 38 Enjoy having the days to yourself for activities? Want to work in a real local's bar? Love rock music? Then zephyr is the place for you. we're Looking for a legend to take the reigns of queenstown's iconic zephyr bar! Duty manager experience preferred. Sound like something you're interested in? To apply, email: HR@REPUBLICQT.CO.NZ Housekeeping Superstars Full-time or part-time, $26 P/H Platinum Queenstown Luxury Villas is a 36-three-bedroom 5-star apartment property located on Fernhill. If you are keen to deliver a high standard of cleaning, hospitality is your passion, and you want to be rewarded for your efforts, we would like to hear from you. We are a supportive, no stress, happy team offering excellent pay rates, paid breaks, ongoing loyalty bonuses, and complimentary machine coffee in the staffroom with biscuits, chocolate, and fresh fruit, all in a property you will be proud to be a part of. Ongoing loyalty bonuses of $1,000 for full-time $500 for part-time, T’s C’s apply. Applicants must be able to work in New Zealand legally. Applications to admin@platinumqueenstown.co.nz servers all rounders bartenders chefs Ever wanted to be a part of something big? Big vibes | Big personalities | Big perks If you’re partial to a party shirt, tequila, and a fast paced work environment to thrive in, come and join the team! Winner! Excellence in People & Culture future.co.nz/careers APPLY HERE
SENIOR CHEF, BREAKFAST CHEF
FRONT OF HOUSE ROLES

Busy daytime winery restaurant located near Arrowtown Open 7 days a week, offering breakfast and long lunches either inside our cosy cottage or outside amongst our landscaped gardens. The Mora Wines cellar door is located here too
You must be in Queenstown to interview.
SENIOR CHEF:
We are looking for a Senior Chef who has experience in top restaurants, can run their own section, someone who thrives in a busy team environment and ts in with our great kitchen culture. This is a permanent full time role with DA T ME O and includes weekend shifts however we are exible with time off Most weeks are 4 days on, 3 days off as we like to promote a good work life balance

Start date asap
BREAKFAST CHEF:
We are looking for a talented breakfast chef who enjoys a fast past early kitchen service, works well under pressure and in a team environment. You'll work alongside another chef. 7am start until 12pm. Flexible on days, it does include weekends Can be a 4 or day week.
Start asap
FRONT OF HOUSE:
Full time part time. Daytime shifts. Great environment and great remuneration Start date mid-late December. Great team, great environment, great remuneration.
Must have experience in hospitality, be professional and personable.
Must have a valid work visa to work in New Zealand.
4 years experience in a fast paced restaurant as a Senior Chef.
Team player, great work ethic, reliable and hard working.
Email deb@mora-artisan.co.nz your CV and cover letter to apply


Arrowtown Four Square Duty Manager

Full Time mainly afternoon evenings
Come work in our busy little supermarket in Arrowtown with great customers.
You will need a current Duty Managers Certi cate or C experience and the ability to get the Duty Managers certi cate
•A team player customer focused
•Punctual, reliable and honest
• Passionate about delivering excellent customer service
• Taking responsibility for supervising evening shifts and organising resources to ensure that Store presentation standards are met and exceeded
Please email your resume to Amanda Colmore-Williams at: Amanda.colmore-williams @foursquare-si.co.nz
FRIED CHICKEN LOVERS
WANTED
Fantastic positions available for those who want a hospitality career with a dynamic and ethical business.
You will be part of a small, dedicated team delivering stand-out customer service and hand-crafting New Zealand's best fried chicken burgers be proud of what you serve. We are growing our brand in 2023 and we need superheroes like you to help us save the world, through organic fried chicken.
Living Wage Employer
Free staff meals
Free parking
Flexible working arrangements

Pro t ncentive Program mmigration accredited
Stand for something good, love what you eat and email the New Colonel darren@lovechicken.co.nz

Scarer and Sale Assistant
Fear Factory Queenstown are looking for an experienced Sales Assistant and Scarer. Average of 25-30 hours a week (full-time), mainly evening work. You will be working with a fun, hard working, scary team, passionate about horror, making people laugh and scream.

•Excellent customer service skills
•Minimum months wih full availability
•Stock management skills
•Cash, eftpos, till and computer skills
•Excellent team player
•Problem solving and communication skills to brief guests and sell merchandise
Interested?
Please email your CV and a cover letter telling us a bit about yourself to queenstown@fearfactory.co.nz
LAKES WEEKLY BULLETIN | 6th December 2022 - 12th December 2022 SITUATIONS VACANT Ph: 03 409 2800 | info@qmg.co.nz | jobfix.co.nz Page 39
R Come join our amazing team and have some fun! Enjoy the following perks when you work with us: - Great atmosphere and team mates - Daily staff meals - Free coffee - all day, every day - Competitive wage - Discounted accomodation in Frankton - Professional career path - Social outings - Flexible roster To apply visit: gasolinealley.joes.co.nz/careers/ or email your cv to birthes@joes.co.nz We’rE lOoKiNg fOr cHeFs - aLl lEvElS dUtY mAnAgEr kItChEn hAnD jOe’s fIvE mIlE jOe’s qUeEnStOwN barista cHeF/Cook
Advertise your job vacancy now at jobfix.co.nz
Cocktail Bartenders
Home to Queenstown's biggest back bar where old school meets new school with the perfect pairing of slick service, homegrown eats and a drinks list that makes you go ‘WOWSAH’.




en


Podcast Host
Full time
The Queenstown App and the iAppNetwork are looking for a fulltime podcast host to develop and produce podcasts for the Wanaka, Central Otago, Queenstown, and Southland markets. The podcast content will centre on what is happening in the respective communities and re ect issues and activities that affect the lives of local people We are looking for somebody with organisation, drive, audio hosting experience, and a passion for community news and information. The host will be counted on to provide a unique, engaged, and thoughtful perspective to the shows format and content and work with producers to liaise and organise guests, identify topics, and help deliver top-level content on a weekly basis.

What You'll Do:
• Collaborate with the producers to identify topics and content for each podcast.
•Source and interview guests.
• Prepare, research, and record up to, but not limited to, four 4 shows per week.
• Continued commitment to maximize skills/assets, and the quality of the podcast.
• Edit audio and prepare the nal product
More About You:
•Must have experience in an audio news or broadcast role.
• Must have a borderline scary knowledge and passion for Otago/ Southland

• A willingness to be coached to develop a unique voice for the podcast
•The ability to work both independently and collaboratively
Apply:
To apply for this role please send a three 3 minute audio application along with your CV to: tony@wanakaapp.nz. Applications close Friday January 13
About Us:
The iAppNetwork is a collaboration of independent hyper-local community publishers operating across New Zealand and Australia producing local news and information.

Recreational Services – Vacancies


Do you enjoy working outdoors and want to work in some of Queenstown’s most beautiful spaces? Then come and join us! We currently have four super cool vacancies for three Facilities Operators and one Handyperson to join our high-performing Queenstown team!
Facilities Operators – Fixed Term, full-time

What does a Facilities Operator do you ask? Well for starters you get to work across some of the most spectacular scenery N has to offer This could be working in Gibbston, one day, Arrowtown the next, or on the lake front in Frankton or Queenstown. The catch is you will need to clean public toilets, BBQs, bus stops and drinking fountains. Pretty simple really. Most days are plane sailing, others you just roll up your sleeves and get on with the job. Housekeeping is no better, at least with us you’re free to enjoy the outdoors.
Handyperson – Permanent, full-time



As a Handyperson you will respond to minor projects and daily call outs for the repair and maintenance of assets in parks and recreation spaces. The work is varied and could include installation of bollards, picnic tables, park signs and park benches, implementing new plantings, as well as hard landscaping. No two days are the same!
We supply all your uniform, PPE, and other goodies after a hard day’s work. The lake is a great spot for lunch, or a swim if you’re keen! We have a great company culture and most get to take a vehicle home also, so there’s savings on getting to and from work – bonus!!
nterested well, you should be please email ebecca at rebecca@rs.kiwi.nz or call 021 743 185
LAKES WEEKLY BULLETIN | 6th December 2022 - 12th December 2022 SITUATIONS VACANT Ph: 03 409 2800 | info@qmg.co.nz | jobfix.co.nz Page 40
o ff Taking sassy cues from brazen big sis Reds Bar, Lil Red is a culinary whiz kid. Cuisine as bold as the décor, she packs pops of quirk and a avourful punch A small intimate 30 seat restaurant, reside, casual and a true dining experience.
Jucy Snooze Queenstown are looking for energetic and enthusiastic people to join us in our re opening! You don’t need experience to work with us We offer staff bene ts from staff accommodation to car rentals and Food & Beverage discounts! Housekeeping Room Attendant tarting from 2 00 an hour Chef roles at all levels Bar Manager Food & Beverage Attendant Please send through your resume to rory_bourke@jucysnooze.co.nz
Email Amy_Ribera@evt.com
FOR YOUR JOB VACANCY FIND THE PERFECT CANDIDATE






LAKES WEEKLY BULLETIN | 6th December 2022 - 12th December 2022 SITUATIONS VACANT Ph: 03 409 2800 | info@qmg.co.nz | jobfix.co.nz Page 41 Customer Services & Fork Lift Operation
40+ hours per week Monday to Friday,
your
free to enjoy
customer service
lifting
)
FOR YOUR CAREER FIND THE PERFECT OPPORTUNITY .co.nz
•
leaving all of
weekends
Queenstown • All you need is great
skills and to be physically fit (heavy
required
• Operate our forklift like a professional Forklift experience is a definite advantage but we have an amazing team who provide all the support you need to learn • Join us to start your long term career within a solid, progressive and growing business To find out what makes us different, get in touch with Rachel to discuss rachel.mansfield@placemakers.co.nz








LAKES WEEKLY BULLETIN | 6th December 2022 - 12th December 2022 SITUATIONS VACANT Ph: 03 409 2800 | info@qmg.co.nz | jobfix.co.nz Page 42 ChefdePartie Provenexperienceinasimilarrole Becreativeandpassionatewhileprovidinghighstandardsof foodquality ExceptionalFoodhygieneknowledgeandpractices Competitiveremuneration Fulltimeposition-day&eveningshifts VisaSponsorshipavailable WearerecruitingnowforatalentedChefdePartietojoinour Ferg'sBarteam.Ourchefsworkwiththebestinlocalproduce andseasonalvariationsaseachplateismadetoperfection.Ifyou haveapassionforgreatfoodandattentiontodetail,thenthisis anexcitingopportunitytobecomepartofourfamousbrand. Applytodaytobecomepartoftheteam. Applyatwww.fergcareers.comoremailhr@fergfoods.com foranyquestions
EMPLOYMENT OPPORTUNITY
HOUSEKEEPING SUPERVISOR
We are looking for an enthusiastic Housekeeping Supervisor with a keen eye for detail to join our team at Pinewood Lodge. Are you a team player with previous housekeeping and or supervising experience?
Wanting to up your experience in the hospitality sector?



If so this the right job for you! Offering accommodation, flexible work hours and available overtime, we look forward to welcoming you here at Pinewood.
Starting Rate: $29.70ph min 30hrs pw.
GENERAL HAND
We are looking for a General Hand who’s not afraid to get their hands dirty to join our Maintenance Team. The right candidate will need to a be a great team player and have experience in similar roles.
A flexible schedule with the willingness to work over time is preferred.
RESPONSIBILITIES
•Provide daily work schedules for the housekeeping team


•Report directly to the housekeeping manager
•Oversee the work of the housekeeping teams and ensure all rooms are finished to the highest quality.
•Using initiative and forward thinking to complete the tasks in an efficient manner. Ensure all daily routines are followed. Be aware of the guest environment and show due consideration when carrying out duties in guest areas.
• Train new staff
•Basic computer knowledge required
•Full drivers licence preferred but not essential.
RESPONSIBILITIES
• Ensure consistent and high quality work across all facilities
•Work alongside skilled craft workers/ technicians in the maintenance and repair of buildings / facilities, grounds and equipment
•Assist with facility projects and continuous improvement progress as directed

•Follow all standard operating procedures in line with Delaware North policies
•Maintain a safe work environment by assisting with implementation of OH&S policies and procedures.
Other duties as directed by the Maintenance Manager.
APPLY
Please apply with your CV to: Kerry Turner kturner@delawarenorth.com
MECHANIC or SMALL ENGINE TECHNICAN
FULL TIME
Southern Lakes Mowers is a locally owned specialist outdoor power equipment store and Husqvarna dealership. We pride ourselves on knowing power equipment inside and out and have a strong focus on our customer service and satisfaction.
We have a fulltime position available for a mechanic or small engine technician to join our modern, well equipped, and busy workshop.
You will be responsible for repairing and servicing mowers and outdoor power equipment as well as providing support to our customers regarding their repairs and purchases.
To be successful in this role, you will be a mechanically uali ed individual with prior hands-on mechanical experience, work well in a small team environment with strong communication skills. Prior experience with outdoor power equipment maintenance and repair is preferred however, not essential.
While this role is advertised as full time, seasonal hours may be negotiable for an applicant with the qualities we are seeking.
Applicants will require New Zealand residency or a valid work Visa and will hold a current New Zealand driver’s licence.
If you are interested in joining our team, please email your cover letter and CV to matt@lakesmowers.co.nz or for a con dential conversation please contact Matt on 03 442 9926

LAKES WEEKLY BULLETIN | 6th December 2022 - 12th December 2022 SITUATIONS VACANT Ph: 03 409 2800 | info@qmg.co.nz | jobfix.co.nz Page 43
Great careers start right here!






We seek exceptional people to deliver an authentic five-star experience to our guests. You will be part of a high-energy, supportive and rewarding work environment.


At heart, we are a vibrant community where employees are fully supported and everyone works closely together to achieve the best for guests and each other.


Millbrook Resort is a completely unique place to work and as an employee, you play a key role in contributing to the ongoing success of this beautiful resort.





LAKES WEEKLY BULLETIN | 6th December 2022 - 12th December 2022 SITUATIONS VACANT Ph: 03 409 2800 | info@qmg.co.nz | jobfix.co.nz Page 44
• LANDSCAPE LABOURER - FIXED TERM • DRIVER • GUEST SERVICE AGENT • FRONT OFFICE ALLROUNDER • GOLF OPERATIONS & FOOD & BEVERAGE ASSISTANT • FOOD & BEVERAGE PERFORMANCE & DEVELOPMENT MANAGER • SALES & EVENTS COORDINATOR • HOUSEKEEPING ATTENDANTS • RESTAURANT OPERATIONS MANAGER • MASSAGE THERAPIST • BEAUTY & MASSAGE THERAPIST • PAINTER/BRUSH HAND • FOOD & BEVERAGE ATTENDANTS • GREENKEEPER • GREENKEEPERS ASSISTANT / LABOURER - FIXED TERM • BARISTA • KITCHEN HANDS
QUEENSTOWN NEW ZEALAND
Your benefits: Our people are our greatest assets, and we love rewarding hard-working team members. At Millbrook, we encourage learning and professional development. When you join the Millbrook family you will also enjoy: Discounted golf, restaurants and spa treatments; Friends & family hotel rates; Discounted gym membership; Onsite car parking; Complimentary sta meals; Daily travel allowance for team members who live more than 25k from the resort; and regular wellbeing workshop. Begin your Millbrook journey today and apply! www.mymillbrook.co.nz You must have a valid NZ Work Visa to apply.
Scan the QR code to find out
our team love
to
each day. Advertise your job vacancy Upload online at jobfix.co.nz FOR YOUR JOB VACANCY FIND THE PERFECT CANDIDATE
WORK IN PARADISE
why
coming
work
jet boat driver






LAKES WEEKLY BULLETIN | 6th December 2022 - 12th December 2022 SITUATIONS VACANT Ph: 03 409 2800 | info@qmg.co.nz | jobfix.co.nz Page 45 2 POSITIONS MID - HIGHSKILLEDROOFER MID - HIGHSKILLED MEMBRANE INSTALLER Are you looking for: • A fresh start to 2023? • An opportunity to earn great money in the stunning Whakatipu Basin? • Achange of scenery, a newcareer or project? • Aworklifebalance to fulfil thoseR & Rand extracurricular interests? No big deal if you do not have a CV, drop us a text021766307or emailhr@roofinghub.co.nz 2531721 • Sense of humour • NZ Driver Licence • 2+ years Roofing/Membrane • Permitted to work in NZ • Love of tools & details • Respect for others • Integrity • Happy to teach Good things to have: • Early finish on Fridays • Career path support • Option of a Fleet Vehicle • Great Roofers to learn from • Paid day off for your birthday • Competitive pay rates • Signing 1 year bonus • Nice friendly staff • Cool projects to work on • Help with accommodation What we offer: We couldbe the Team for you! A popular local’s pub with a variety of dishes to suit all. A fast-paced kitchen, working alongside a fun & social team! To find out more head to franktonarmtavern.co.nz For this role, you must have recent a la carte/ commercial kitchen experience Benefits you will receive include: • Competitive pay rate • Supportive and fun team • Staff pricing across 10 venues • Free staff meal when on shift To apply, please email hr@republicqt.co.nz a CV and cover letter. We look forward to hearing from you. we’re hiring! experienced Chef/Cook • Career pathways • On the job training • Accommodation support if needed Public Kitchen and Bar Finz Seafood and Grill and Bella Cucina are looking for superstars who genuinely care and want to join an amazing team to help deliver memorable experiences for our guests. We are hiring in the following positions: Bartenders s ff Duty Manager Restaurant Manager Commis Chef Chef de Partie Sous Chef Head Chef Kitchenhands We offer: •Amazing pay rates. •Bonus's. •Exceptional team spirit. • Professional development and opportunities for growth. •Accommodation available. Apply NOW at: https://waidininggroup.bamboohr.com/jobs
SERVICE
CUSTOMER
MANAGER
This is an exciting opportunity to become a Jet Boat Driver with the world’s first commercial Jet Boating company. To succeed in this role you must be physically fit, have fantastic customer relations, be prepared to work long hours in all weather conditions, some mechanical knowledge and a full clean NZ Drivers Licence. This is a minimum two-year fixed term contract, so NZ residents need only apply. Training options are available for an immediate start. A fit and proper person check, and pre-employment drug testing will be part of the interview process for potential candidates. If you want to be part of a fun team, respond well to pressure, love working outdoors and enjoy interacting with people – then please contact us today for further information. For more information and to apply please email your CV to brett@kjet.co.nz Advertise your job vacancy | Upload online at jobfix.co.nz
Do you enjoy meeting people? Do you have attention to detail? Do you enjoy working in a fun/relaxed environment?

If you have answered yes to all the above questions then you may be the person we are looking for to fill our position of Receptionist / Admin Support in our ueenstown Office.
ou could be a school leaver or someone returning to the workforce wanting a role with fewer hours. ue to continued growth in the company there is now the need for administrative assistance in our ueenstown office.
This part time role will be approximately 15-20 hours per week, envisaged as around am or pm each day, or possibly longer worked over four days. There is flexibility for the right candidate
Duties include:
•Greeting visitors and answering phones

• etting up obs and general staff support
• ord document assistance for engineers


• ompletion of ouncil documents s and s when requested by engineers

• anage stationery and other office supplies

•Filing
We are looking for someone with the following qualities:
• A team player with good communication skills and a can do attitude
• Organised and able to manage time effectively
•With good MS Word skills
•Who has attention to detail
• Experience with orkflowmax an advantage but not essential
What we offer:
• elaxed working environment and friendly staff


• lenty of support around you
JOIN THE MOVEMENT
and be a part of Republic Hospitality Group
•Tired of being bored at work?
•Want to make your Queenstown life epic!
•Looking to meet a fun and friendly crew?
Republic Hospitality Group has 10 venues in Queenstown, and we o er casual, part-time and full-time work. So whether it’s bar, restaurant or kitchen work you’re interested in, we’ve got it available at all levels



Our perks are pretty hard to beat:
• Sta pricing (did someone say great deals on food & drink?)

• Sta accommodation options
• Epic sta parties
• Great sta incentives
• A trusting culture
• Competitive pay
• Free sta meals

• Training and upskilling
• A welcoming and friendly team
Republic is a finalist in the NZ Hospitality Awards for Excellence in People & Culture for a reason. Get in touch and join us today, email HR@republicqt.co.nz and tell us what you’re looking for.

Check out our venues at www.republichospitality.co.nz
• Ongoing social activities If you feel that this role sounds like you, then please apply with your CV by emailing info@sullivanhall.co.nz Are you… a Little Odd? Join the club. odd saint is hiring. We are pushing boundaries and breaking rules. Take everything you know about breakfast and lunch, then forget it. We are changing the game. Come and be a part of something special.

LAKES WEEKLY BULLETIN | 6th December 2022 - 12th December 2022 SITUATIONS VACANT Ph: 03 409 2800 | info@qmg.co.nz | jobfix.co.nz Page 46
rounders •Kitchen Hands •Chefs •Duty Managers •Baristas To apply please scan the QR code or visit future.co.nz Winner! Excellence in People & Culture Looking for STAFF? Advertise your JOB vacancy with us! AN ADVERT THIS SIZE WOULD COST ONLY $249.34+GST AND INCLUDES THE VACANCY ON JOBFIX FOR 7 DAYS
•All
Crowning Shot
Seymour


LOVE THIS SHOT? Follow @momentasaurus to see more by Jessica














50% off. Sleepyhead Chiropractic ranges. 1,000 days interest free* On purchases $999 & over 'til 25.12.22 Comfort Guarantee Proudly Local Warranty Shop Safe Come see your Local Sleep Specialists Phone 03 441 4554 | www.bedsrus.co.nz Building 10, Shop 06/12 Hawthorne Drive, Remarkables Park Shopping Centre Pro Locally owned and operated We are hiring. Enquire within ricky@bedsrus.co.nz

by Sue Fea
by Sue Fea





 Joan acting the goat on stage as Mrs Abominable in the 1980s
Joan in the 1980s with her donkeys and goats
Joan and her beloved pet donkey, Barty, who lived until 26. Photo: Jo Boyd
Joan acting the goat on stage as Mrs Abominable in the 1980s
Joan in the 1980s with her donkeys and goats
Joan and her beloved pet donkey, Barty, who lived until 26. Photo: Jo Boyd




























 By Paul Taylor
By Paul Taylor














































































































































































































































































































































































































